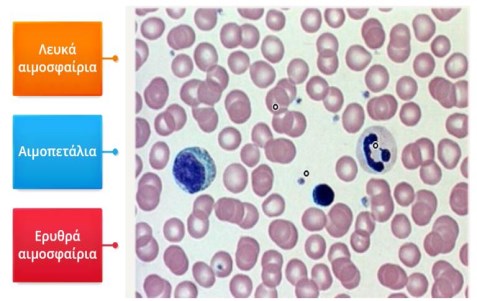

Α
ρ.
Τ
εύχους
1
-
Ιού
λι
ος
2024
Σ
ημε
ίω
μα
Συντακτικής Ομάδας
Τεύχος 1 Ιούλιος 2024
Σχ
ετ
ικ
ά
με
το
Περ
ι
οδ
ικ
ό
Το "ΕΥΡΗΚΑ" είναι ένα
περιοδικό αφιερωμένο στην
πειραματική διδασκαλία των
Φυσικών Επιστημών.
Με την έκδοσή του, η Πανελλήνια
Ένωση Υπευθύνων Φυσικών
Επιστημών (ΠΑΝ.Ε.Κ.Φ.Ε.) φιλοδοξεί
να προσφέρει χρήσιμα και ποιοτικά
άρθρα που να ενημερώνουν και να
εμπνέουν, προβάλλοντας την αξία της
πειραματικής διδασκαλίας.
Προσκαλούμε ενδιαφερόμενους
αρθρογράφους να συμμετάσχουν στη
δημιουργική μας ομάδα, ανοιχτή σε
καινοτόμες ιδέες και καλές πρακτικές.
Τα άρθρα κρίνονται από
επιστημονική ομάδ
εξασφαλίζοντας έτσι την ποιότητα και
την εγκυρότητα του περιεχομένου του
- εκδίδεται ISSN, παρέχοντας
επίσημη και επαγγελματική
αναγνώριση.
Σας ευχαριστούμε που διαβάζετε το
ΕΥΡΗΚΑ!
-----------------------------------------------------------
Εκ
δότης
:
ΠΑΝ
. Ε.Κ.Φ.Ε.
Συντονιστές συντακτικής ομάδας:
Μανουσάκη Κλ., Χαλκιαδάκης Κ.
Συντακτική ομάδα:
Βάρθης Ε., Κυριαζοπούλου Σ.,
Κωνσταντινοπούλου Β., Λάζος Π.,
Μουρούζης Π., Παλούμπα Έ.,
Παναγιωτίδης Ν., Παπαδέλη Έ., Τσακίρη
Μ.
Σ
το
τρέ
χ
ον
τεύ
χ
ος
:
Βοηθοί σύνταξης :
Παλούμπα Έ. , Παπαδέλη Έ.
Επιμέλεια άρθρων:
Βάρθης Ε. , Μανουσάκη Κλ.
Ψηφιακή επεξεργασία:
Βάρθης Ε.
Οπισθόφυλλο:
Λάζος Π., Χαλκιαδάκης Κ.
Ιδιαίτερα ευχαριστούμε τη γραφίστρια
Ιωάννα Ηλιακάκη (Γραφίστικο) για τη
συνεισφορά της στον σχεδιασμό του
λογότυπου του περιοδικού και του
εξωφύλλου
Τα τελευταία χρόνια, όλο και συχνότερα, όταν συστηνόμαστε, υπάρχει
μια αντίδραση σαν την παρακάτω:
“Ώστε είστε καθηγητής Φυσικής; Να ξέρετε, για μένα η Φυσική ήταν το
χειρότερο μάθημα στο Λύκειο!”. Στη θέση της Φυσικής μπορείτε να βάλετε
οποιοδήποτε άλλο μάθημα των Φυσικών Επιστημών.
Στην αντίπερα όχθη από τη δήλωση αυτή, βρίσκεται το χαμόγελο των
μαθητώντου Δημοτικού,ότανεπισκέπτονταιτοΕ.Κ.Φ.Ε. και, με γουρλωμένα
μάτια, παρακολουθούν τα πειράματα.
Πώς γίνεται, λοιπόν, μέσα σε λίγα χρόνια, ο ενθουσιασμός για τα
μαθήματα των Φυσικών Επιστημών, να μετατρέπεται σε απέχθεια;
Παράλληλα, παρατηρούμε κι ότι η αμφισβήτηση της αξίας και την
εγκυρότητας της επιστημονικής γνώσης “καλά κρατεί”.
Με αυτό τον προβληματισμό προχωράμε στην έκδοση του περιοδικού
“Εύρηκα”, θεωρώντας ότι μέσω της εργαστηριακής εμπειρίας, οι μαθητές
μπορούν να αγαπήσουν τις μεθόδους με τις οποίες οι επιστήμονες
“ανακρίνουν τη Φύση” για να αποσπάσουν πολύτιμες απαντήσεις.
Το περιοδικό μας προσπαθεί να μεταφέρει στον αναγνώστη τη χαρά της
ανακάλυψηςμετηνπειραματική διερεύνηση, τηνέκπληξημιας ασυνήθιστης
παρατήρησης, το αίσθημα της αποκάλυψης μιας νέας ιδέας μέσα στο
εργαστήριο!
Αυτά τα συναισθήματα δεν δημιουργούνται από την
απομνημόνευση τύπων, από την επίλυση ασκήσεων ή
από τη χρήση ψηφιακών προσομοιώσεων χωρίς
αντιστοίχιση στον πραγματικό κόσμο.
Π
ΕΡ
Ι
Ε
Χ
Ο
ΜΕ
ΝΑ
Η
δ
ι
δασ
κ
αλ
ί
α
τ
ω
ν
Φ
υσ
ικώ
ν
επ
ι
στημ
ώ
ν
:3
(
Ν
ίκ
ος
Αναστασά
κ
ης
)
Ηλε
κ
τρο
φ
όρος
:9
(Β
αγγέλης
Β
άρ
θ
ης
)
Μ
ε
πε
ι
ράματα
ηλε
κ
τρ
ι
σμού
ανα
κ
αλύπτουμε
τη
δομή
της
ύλης
:18
(
Αναστασ
ί
α
Γ
κι
γ
κ
ούδη
–
Ν
ίκ
η
Μ
αμ
ζ
ερ
ί
δου
)
Προσομο
ιώ
νοντας
τη
λε
ι
τουργ
ί
α
του
κ
υ
κ
λο
φ
ορ
ικ
ού
συστήματος
κ
α
ι
τη
σύσταση
του
α
ί
ματος
:
2
3
(Έ
ρη
Παπαδέλη
)
Σ
χ
ολ
ικ
ή
Σ
απ
ω
νοπο
ί
ηση
:
2
8
(Σ
ταυρούλα
Γ
ατή
- Ε
λένη
Παλούμπα
)
Ανάλυση
βί
ντεο
:33
(Β
ασ
ί
λης
Νούσης
)
Αναλυτ
ικ
ός
Π
ί
να
κα
ς
περ
ι
ε
χ
ομέν
ω
ν
:
4
0
Τεύχος 1
,
Ιούλιος 2024
Η
δ
ι
δ
α
σκ
α
λ
ί
α
τ
ω
ν
Φ
υσ
ι
κ
ώ
ν
ε
π
ι
στημ
ώ
ν
:
προσαρμογή
στη
σ
χο
λ
ικ
ή
πραγματ
ικ
ό
-
τητα
του
Γ
εν
ικ
ού
Λυ
κ
ε
ί
ου
Νίκος Αναστασάκης
M.Ed. Φυσικός, υπεύθυνος Ε.Κ.Φ.Ε. Χανίων
Περίληψη
Λέ
ξ
ε
ι
ς
Κ
λε
ι
δ
ι
ά
:
φ
υσ
ικ
ήλυ
κ
ε
ί
ου
,
εργαστήρ
ι
ο
,
πε
ι
ραματ
ικ
ήδραστηρ
ι
ότητα
,
εργαστηρ
ι
α
κ
ή
άσ
κ
ηση
Τ
ο
Σχ
ολ
ικ
ό
Ε
ργαστήρ
ι
ο
Φ
υσ
ικώ
ν
Ε
π
ι
στημ
ώ
ν
,
αν
κ
α
ι
τυπ
ικ
ά
περ
ι
λαμ
β
άνετα
ι
στ
ι
ς
υποδομές
του
Γ
εν
ικ
ού
Λυ
κ
ε
ί
ου
,
στην
πρά
ξ
η
χ
ρησ
ι
μοπο
ι
ε
ί
τα
ι
ελά
χι
στα
ή
κ
α
θ
όλου
.
Ω
στόσο
,
ο
πε
ι
ραματ
ι
σμός
κ
α
ι
η
αλληλεπ
ί
δραση
με
τον
πραγματ
ικ
ό
κ
όσμο
ε
ί
να
ι
θ
εμελ
ιώ
δες
συστατ
ικ
ό
γ
ι
α
τη
δ
ι
δασ
κ
αλ
ί
α
τ
ω
ν
Φ.Ε.. Έ
τσ
ι,
σε
μ
ι
α
προσπά
θ
ε
ι
α
να
ζω
ντανέ
ψ
ε
ι
ηεργαστηρ
ι
α
κ
ήδ
ι
δα
κ
τ
ικ
ήπρα
κ
τ
ικ
ή
,
προτε
ί
νουμεορ
ι
σμένες
δραστηρ
ι
ότητες
,
ενδε
ικ
τ
ικ
ά
γ
ι
α
τη
Φ
υσ
ικ
ή
της
Α
’
Λυ
κ
ε
ί
ου
.
Η
δ
ι
δασ
κ
αλ
ί
α
της
κ
ά
θ
ε
ενότητας
του
αναλυτ
ικ
ού
προγράμματος
εμπλουτ
ίζ
ετα
ι
με
απλές
δραστηρ
ι
ότητες
που
μπορούν
να
γ
ί
νουν
μέσα
στην
τά
ξ
η
από
τους
μα
θ
ητές
, ώ
στε
να
ε
φ
αρμόσουν
ή
κ
α
ι
να
«
ανα
κ
αλύ
ψ
ουν
»
τη
θ
ε
ω
ρ
ί
α
που
δ
ι
δάσ
κ
οντα
ι. Μ
ετά
την
ολο
κ
λήρ
ω
ση
της
ενότητας
, χ
ρησ
ι
μοπο
ι
ε
ί
τα
ι
το
Σχ
ολ
ικ
ό
Ε
ρ
ανα
κ
ε
φ
αλα
ιω
τ
ικ
ής
εργαστηρ
ι
α
κ
ής
άσ
κ
ησης
.
Φυσική
Το 2015 (σύμφωνα με ερωτηματολόγιο που δόθηκε από
το Ε.Κ.Φ.Ε. Χανίων), στα ΓΕ.Λ του Ν. Χανίων και σε
σύνολο 16 εργαστηρίων, τα 8 χρησιμοποιούνταν ως
αίθουσες διδασκαλίας/προβολών για μαθήματα εκτός
των Φυσικών Επιστημών ενώ από τα υπόλοιπα, σχεδόν
τα μισά χρησιμοποιούνταν 2-3 φορές τον μήνα. Μόνο
σε 3 (επαρχιακές) σχολικές μονάδες ο αριθμός των
μαθητώνπουκαλούνταννασυμμετάσχουνστις
εργαστηριακές δραστηριότητες ήταν μικρότερος του 18.
Συνολικά, πλήρη αξιοποίηση είχε μόλις το 25% των
εργαστηρίων του νομού.
Σήμερα η κατάσταση δεν έχει βελτιωθεί. Έχοντας
μεσολαβήσει και η περίοδος της πανδημίας με την
αντίστοιχη έντονη χρήση των ψηφιακών μέσων, το
εικονικόεργαστήριοσυχνάεπιστρατεύεται
παραγκωνίζοντας το ζωντανό.
Η εργαστηριακή διδασκαλία και η διερευνητική
μέθοδος αν και θεωρητικά συμπεριλαμβάνεται στα
ΝΠΣ, ουσιαστικά απαξιώνεται συνεχώς και μία ένδειξη
για αυτό είναι ότι την περίοδο 2023-24, ένας μεγάλος
αριθμός Ε.Κ.Φ.Ε. (περίπου το 1/3) δεν στελεχώθηκαν
και είναι κλειστά.
Στον αντίποδα, το πολύ έντονο ενδιαφέρον των
μαθητών και η αποτελεσματικότητα της εμπλοκής τους
με την εργαστηριακή πρακτική είναι εμφανή κατά τις
εκπαιδευτικές επισκέψεις τους στο Ε.Κ.Φ.Ε. Χανίων.
Ήδη φέτος (στα μέσα της σχολικής χρονιάς), έχουν
ολοκληρωθεί επισκέψεις 900 μαθητών/τριών και 140
εκπαιδευτικών ενώ, σύμφωνα με τον προγραμματισμό
που υπάρχει, θα ξεπεράσουν τους 1500. Σημειώνεται
ότι όλοι οι επισκέπτες συμμετέχουν κατά ομάδες στην
εκτέλεσημετωπικώνεργαστηριακώνασκήσεων
Φυσικής, Χημείας και Βιολογίας.
δημιουργική παιδαγωγική
διερευνητικήςπρακτικής,
και γενικότερα για μια
προσέγγισημέσωτης
προτείνουμε:
α. ενσωμάτωση του εργαστηρίου στην
διδασκαλία μέσω δραστηριοτήτων «τάξης»
με απλά υλικά ή/και χρήση των ΤΠΕ
β. εργαστηριακές ασκήσεις στο σχολικό
εργαστήριοΦ.Ε.μεχρήσητου
εργαστηριακού εξοπλισμού.
Τα παραδείγματα που ακολουθούν αφορούν τη
Φυσική της Α’ Λυκείου όμως η πρόταση μπορεί να
επεκταθείμεκατάλληλεςτροποποιήσεις(π.χ
μικροκλίμακα) και σε άλλα διδακτικά αντικείμενα.
Αρχικά, ενσωματώνουμε πειραματικές δραστηριότητες
στο καθημερινό μάθημα. Χρησιμοποιούμε υλικά και
υποδομές που ήδη βρίσκονται στην τάξη (θρανία,
βιβλία, στυλό, σελίδες χαρτί, οδηγίες & σχήματα στον
πίνακα, βιντεοπροβολέας – διαδίκτυο, tablet κ.ά.), σε
συνδυασμό με λιγοστά εργαστηριακά αντικείμενα που
μπορεί να έχει μαζί του ο/η εκπαιδευτικός (βαρίδια,
νήμα,χρονόμετρα,δυναμόμετρακ.λπ.).Οι
Εισαγωγή
να βασικό συστατικό της διδασκαλίας των
Φυσικών Επιστημών είναι το πείραμα, η
αλληλεπίδραση του μαθητή με τον πραγματικό
κόσμο [1],[2],[3],[4]. Αυτό είναι δύσκολο στο σημερινό
Λύκειο, με τμήματα 20-25 ατόμων, στοχοθεσία
εστιασμένη στις Πανελλήνιες εξετάσεις, εργαστηριακές
αίθουσες σε καθεστώς αναστολής, εκπαιδευτικούς που
τρέχουν να καλύψουν το ωράριο και την ύλη,
απογοητευμένους και συχνά υπερ-απασχολημένους
(εκτός του αντικειμένου τους). Κυρίως όμως, με
μαθητέςπουπολύ
συχνάβλέπουντις
Επιστήμες αδιάφορα
ή ως αναγκαίο κακό
Φυσικές
για την
Επέκταση του εργαστηρίου στη σχολική τάξη
εισαγωγή τους σε μία σχολή.
Για τη διδασκαλία των Φ.Ε. στο Γενικό Λύκειο αλλά
Έ
4
Τεύχος 1
,
Ιούλιος 2024
Εικόνα 1.Γυάλινος σωλήνας με νερό και φυσαλίδα αέρα
μαθητές/τριεςκαθοδηγούνταιμέσωαπλώνκαι
σύντομωνφύλλωνεργασίας καιεφαρμόζουν ή
ανακαλύπτουν στην πράξη τη θεωρία που έχουν ήδη
διδαχθεί ή διδάσκονται.
Μετά την ολοκλήρωση της κάθε διδακτικής ενότητας,
μπορούν να ασκηθούν και σε εργαστηριακές ασκήσεις
μεγαλύτερης κλίμακας, «εργαστηρίου».
Οι πειραματικές δραστηριότητες
Οι ακόλουθες προτάσεις προέρχονται από διδασκαλίες
μέσα στη σχολική τάξη και από ιδέες – προτάσεις
συναδέλφων στα Λύκεια του νομού Χανίων [5],[6], [12].
Είναι δομημένες έτσι, ώστε να ακολουθούν τη ροή της
διδασκαλίας του σχετικού αντικειμένου και να γίνονται
παράλληλα με το μάθημα. Σκοπός τους είναι η
κατανόηση των Φυσικών Εννοιών και μεγεθών και έτσι
δεν δίνεται ιδιαίτερη έμφαση στην ακρίβεια των
μετρήσεων.
Ευθύγραμμη Ομαλή Κίνηση
κλειστό γυάλινο σωλήνα που περιέχει νερό και μία
φυσαλίδα αέρα, Εικόνα 1, για να παρατηρήσουν την
κίνηση [1]. Σημειώνουν τις διαδοχικές θέσεις της
φυσαλίδας,υπολογίζουντηνταχύτητάτηςκαι
φτιάχνουν τοδιάγραμμα μετατόπισης – χρόνου.
Παράλληλα παρατηρούν και σχετική προσομοίωση [10].
B, στο εργαστήριο: Χρησιμοποιούμε ένα παιδικό
παιχνίδι – τρενάκι, Εικόνα 2, που κινείται με σταθερή
ταχύτητα,συνδεδεμένομετηχαρτοταινίατου
χρονομετρητή [7]. Οι μαθητές χρησιμοποιούν τις
ενδείξεις της χαρτοταινίας για να παρατηρήσουν τον
νόμο της κίνησης (ίσες αποστάσεις σε ίσα χρονικά
διαστήματα). Η κατασκευή των διαγραμμάτων
𝑥 − 𝑡
και
𝜐 − 𝑡
μπορεί να γίνει:
•
Με χρήση της χαρτοταινίας όπως προτείνεται
στον σχολικό εργαστηριακό οδηγό για την
επιταχυνόμενη κίνηση [8].
•
Με χρήση χαρτιού μιλιμετρέ και πίνακα τιμών
όπου σημειώνουν τις ενδείξεις της
χαρτοταινίας.
Ευθύγραμμη Ομαλά Μεταβαλλόμενη κίνηση
Α, στην τάξη: Χρησιμοποιείται ως κεκλιμένο επίπεδο
το θρανίο. Επιπλέον, τα tablet που βρίσκονται στα
σχολεία μπορούν να χρησιμοποιηθούν ως χρονόμετρα
αλλά και να εμφανίζουν τυχόν ψηφιακό υλικό (μέσω
QR-code).
Οι μαθητές/τριες ανά ομάδες (π.χ. ανά 2 ή 4) με τη
βοήθεια χαρτοταινίας σημειώνουν καθορισμένα μήκη
πάνω στο θρανίο, ώστε να μπορέσουν να μελετήσουν
εύκολα την κίνηση.
Ένας μικρός κύλινδρος (π.χ. βαρίδι εργαστηρίου)
αφήνεται να κυλίσει. Ακολουθώντας τις οδηγίες των
Α, στην τάξη: Οι μαθητές χρησιμοποιούν διάταξη με
φύλλωνεργασίας,αρχικάελέγχουντιςχρονικές
διάρκειες ίσων μετατοπίσεων και τις μετατοπίσεις για
ίσα χρονικά διαστήματα.
Καταγράφουν απόσταση - χρόνο και φτιάχνουν τα
διαγράμματα
𝛥𝑥 − 𝑡 & 𝛥𝑥 – 𝑡
2
.
Παρακολουθούν μία προσομοίωση της κίνησης
φτιαγμένη με κατάλληλο λογισμικό (π.χ. Μodellus,
Η.Σιτσανλής), όπου φαίνονται οι διαδοχικές θέσεις του
αντικειμένου [11], φτιάχνουν το διάγραμμα
𝜐 − 𝑡
.
Β,στοεργαστήριο:Μπορούνναγίνουν
εργαστηριακές ασκήσεις με διαφορετικές απαιτήσεις
και επίπεδο δυσκολίας. Η κίνηση εκτελείται είτε από
Εικόνα 2.Παιδικό αμαξάκι μπαταρίας
εργαστηριακό αμαξάκι και βαρίδι, είτε με μπίλια σε
5
Τεύχος 1
,
Ιούλιος 2024
Εικόνα 5.Παιδικό τραινάκι, δυναμόμετρο και επιφάνειες,
για τη μελέτη των ιδιοτήτων της τριβής
Εικόνα 4. Διατάξεις για τον υπολογισμό της συνισταμένης
δύναμης (αριστερά) και συνιστώσας δύναμης (δεξιά)
Δυνάμεις στη φύση
Τριβή
Α, στην τάξη: Ο/Η εκπαιδευτικός χρησιμοποιεί ένα
αντικείμενο με επιφάνειες διαφορετικής υφής (π.χ.
κύβος σειράς οργάνων μηχανικής). Με δυναμόμετρο ή
μέσω του παιδικού παιχνιδιού – τραινάκι, Εικόνα 4,
ασκεί δύναμη ώστε ο κύβος να κινείται με σταθερή
ταχύτητα.
Οι μαθητές μέσω φύλλων εργασίας καταγράφουν την
τιμή της τριβής για τις διάφορες επιφάνειες του κύβου
(καθώςαυτήείναιίσημετηδύναμητου
δυναμομέτρου), τους παράγοντες από τους οποίους
εξαρτάται και υπολογίζουν το συντελεστή της. Β, στο
εργαστήριο: Χρησιμοποιείται το κεκλιμένο επίπεδο της
σειράς οργάνων μηχανικής, Εικόνα 6, σε μια παραλλαγή
τηςκλασικήςεργαστηριακήςάσκησηςόπου
μεταβάλλοντας την γωνία κλίσης υπολογίζουμε τον
συντελεστή (οριακής) τριβής. [8].
γίνεται με χρονομετρητή, με φωτοπύλες, με αισθητήρες
(Μul
t
ilog, arduino, κινητό/phyphox) ή με βιντεοσκόπηση
και ανάλυση μέσω του λογισμικού Tracker. Στην Εικόνα
3 δίνεται ενδεικτικό διάγραμμα από δεδομένα που
κατέγραψε το Mul
t
ilog.
κεκλιμένο επίπεδο.
Η
καταγραφή των μετρήσεων
Δύναμη και κίνηση
Εικόνα 3. Διάγραμμα μετατόπισης - χρόνου, από τη
συσκευή Mul
t
ilog
Α, στην τάξη
:
Οι μαθητές έχουν ανά δύο ή τρείς στα
θρανία τους την διάταξη που φαίνεται στην Εικόνα 7. Η
κατασκευή είναι απλή και υλοποιείται με τρία βιβλία,
ένα καλαμάκι αναψυκτικού, ένα ξυλάκι ως άξονα (π.χ
από σουβλάκι) ένα βαρίδι και νήμα. Η κίνηση με την
οποία ασχολούνται είναι αυτή του βαριδιού. Το βιβλίο
που συνδέεται στο άλλο άκρο του νήματος χρησιμεύει
Α, στην τάξη: Οι διατάξεις που χρησιμοποιούνταιως «φρένο» [5]. Σκοπός είναι η παρατήρηση της κίνησης
στήνονται στην έδρα από τον εκπαιδευτικό, όπως αυτέςως αποτέλεσμα της επίδρασης σταθερών δυνάμεων
που αναπαριστώνται στην Εικόνα 5. Οι μαθητές
σχολιάζουνκαικαταγράφουντιςδυνάμειςπου
ασκούνται,τιςσχεδιάζουν στα τετράδια τους
υπολογίζουν την συνισταμένημε τοννόμο του
παραλληλογράμμου και αναλύουν σε συνιστώσες.
6
Τεύχος 1
,
Ιούλιος 2024
Εικόνα 6. Διάταξη με απλά υλικά όπου το βαρίδι κινείται
με την επίδραση σταθερών δυνάμεων .
Εικόνα 7. Εξαρτήματα της διάταξης κεκλιμένου επιπέδου
από την σειρά οργάνων μηχανικής
(βάρος,τριβή)καιηαντίστοιχηεφαρμογήτου
θεμελιώδη νόμου της μηχανικής.
Μετρούν με δυναμόμετρο την μάζα του βαριδιού και
σχεδιάζουν τις δυνάμεις που του ασκούνται όταν αυτό
ισορροπεί. Ελευθερώνουν το σύστημα έτσι ώστε το
βαρίδι να αρχίσεινα κινείται και καταγράφουν τον
χρόνο που χρειάζεται για να κατέβει συγκεκριμένη
απόσταση (π.χ. δύο φορές το πλάτος του βιβλίου της
Φυσικής είναι περίπου 40 cm). Σχολιάζουν το είδος της
κίνησης και καταγράφουν την εξίσωση της μετατόπισης.
δυνάμεωνμε
Χρησιμοποιώντας την μέτρηση του χρόνου και της
απόστασης υπολογίζουν την επιτάχυνση. Εφαρμόζοντας
τον θεμελιώδη νόμο της μηχανικής, υπολογίζουν τη
συνισταμένη δύναμη που δέχεται το βαρίδι αλλά και
την τάση που του ασκείται από το νήμα. Μπορεί να γίνει
συζήτηση για την μεταβολή της τιμής της, σε σχέση με
την κατάσταση ισορροπίας.
Αν ο χρόνος για την ολοκλήρωση της δραστηριότητας
στην τάξη δεν είναι αρκετός, ολοκληρώνουν την
επεξεργασία του φύλλου εργασίας στα σπίτια τους.
Β, στο εργαστήριο: Μπορούν να επαναλάβουν την
προηγούμενηδραστηριότηταχρησιμοποιώντας
εργαστηριακό εξοπλισμό (τροχαλία, εργ. αμαξίδιο κλπ.).
εξισώσεις των
Σε κάθε περίπτωση εφαρμόζουν τις
κινήσεωνκαιτουςνόμουςτων
πειραματικά (πραγματικά) δεδομένα.
Αξιολόγηση της διδακτικής στρατηγικής
Ηπροαναφερθείσαδιδακτικήπροσέγγιση
εφαρμόστηκε το 2015 σε επαρχιακό ΓΕΛ του νομού
Χανίων. Ηαποτίμηση της οδήγησε σεκάποιες
παραλλαγές που λήφθηκαν υπόψη στο παρόν άρθρο.
Δόθηκε ένα ερωτηματολόγιο σε 32 μαθητές/τριες Α’
Λυκείου. Το 78% των μαθητών απάντησαν ότι ο
συγκεκριμένος τρόπος διδασκαλίας τους βοηθάει στην
κατανόηση των εννοιών που διδάσκονται, ενώ η
διδασκαλία είναι συνολικά πιο ενδιαφέρουσα και
ευχάριστη (56% και 35% αντίστοιχα).
Μίαεπιπλέονιδέαπουέχειαποδειχθεί
αποτελεσματική κατά την εφαρμογή της σε διδακτικές
δράσεις του Ε.Κ.Φ.Ε. Χανίων, είναι η χρήση ψηφιακών
φύλλων εργασίας μεερωτήσεις βελτιωτικής
ανατροφοδότησης / καθοδήγησης. Καθώς το μεγάλο
ποσοστό των σχολείων κατά την περίοδο της πανδημίας
εξοπλίστηκανμεtablet,είναιευκαιρίαγιατην
αξιοποίηση τους.
Συμπεράσματα
Πριν 200 χρόνια ο Κ. Μ. Κούμας [13] έλεγε:
«Πειραματικά όργανα μεταχειρίζομαι καθ΄ εκάστην εις
τας παραδόσεις μου». Τα λόγια αυτά αποτελούν μέρος
του σημερινού λογότυπου του Ε.Κ.Φ.Ε. Χανίων και
βέβαια, όχι τυχαία.
Σήμερα, παρά το ότι τα περισσότερα σχολεία
διαθέτουν εργαστηριακό εξοπλισμό ενώ οι ΤΠΕ έχουν
7
Τεύχος 1
,
Ιούλιος 2024
γίνειβασικόσυστατικότηςυποδομήςτους,η
διδασκαλία της Φυσικής γίνεται κυρίως ως διάλεξη
συνοδευόμενη από(συχνά δυσνόητες) ασκήσεις,
διανθισμένη ενίοτε με παθητικά video που μετατρέπουν
τον βιντεοπροβολέα σε σύγχρονο μαυροπίνακα.
Η υπόθεση, ο πειραματισμός, η επιβεβαίωση, η
επιστημονική προσέγγιση πρέπει να είναι αναπόσπαστο
κομμάτι της διδασκαλίας της Φυσικής, όχι μόνο στο
εργαστήριο αλλά και στην τάξη. Θέλουμε η πειραματική
διδασκαλίανα«ανθίσει»καιμέσαστηντάξη,
βοηθώντας τους μαθητές μας να κατανοήσουν την
Φυσική μέσω μια βασικής της αρχής: αυτήν της
αλληλεπίδρασης!
[1].Κουτσούμπα, Μ. (2016). Σχεδιάζω δραστηριότητες και ασκήσεις αυ-
τοαξιολόγησης στο εκπαιδευτικό υλικό για αποτελεσματική μάθηση.
Σχεδιασμός&ανάπτυξηεκπαιδευτικούυλικού,ΕΑΠ.
[2].Σκουμιός, Μ. (2012a). Αντιλήψεις των μαθητών για έννοιες των Φυσι-
κώνΕπιστημώνκαιδιδακτικήτουςαντιμετώπιση.
[3].Πανταζή, Γ., & Τσαπαρλής, Γ. (2011). Μπορούν κατάλληλες διδακτικές
προσεγγίσεις να προωθήσουν την εννοιολογική αλλαγή; Ανασκόπηση
επιλεγμένης βιβλιογραφίας επί της κατανόησης της κινηματικής στη
μέση εκπαίδευση. 372–381.
[5].Αναστασάκης Ν. (2017). Εργαστηριακός Οδηγός Φυσικής Α’ Λυκείου.
Χανιά
[6].Κουμαράς,Π. (2000). Πειράματα με Απλά Υλικά (1η έκδ.). ΟΕΔΒ.
[7].Μπισδικιάν Γ., Μολοχίδης Τ. (2002). Κατάλογος Οργάνων και συ-
σκευών Εργαστηρίου Φυσικών Επιστημών Αθήνα: ΟΕΔΒ.
[8].Βλάχος Ι. Γραμματικάκης Ι., Καραπαναγιώτης Β., Κόκκοτας Π., Περι-
στερόπουλος Π., Τιμοθέου Γ (2013). Φυσική Α’ Λυκείου. Αθήνα:
Ινστιτού-το Τεχνολογίας και Υπολογιστών Διόφαντος
[9]. Αντωνίου Ν., Δημητριάδης Π., Καμπούρης Κ., Παπαμιχάλης Κ., Παπα-
τσίμπα Λ. (2013). Φυσική Β’ Γυμνασίου. Αθήνα: Ινστιτούτο Τεχνολογίας
και Υπολογιστών Διόφαντος
Δικτυακοί τόποι:
[10]. PhET Colorado, κινούμενος άνδρας Ημερομηνία προσπέλασης:
23/2/2024
[11]. Η. Σιτσανλής:
“επιτάχυνση» Ημερομηνία προσπέλα-
σης: 24/2/2024
[12]. Ε.Κ.Φ.Ε. Χανίων, Εκπαιδευτικό Υλικό Δευτεροβάθμιας:
Ημερομηνία
προσπέλασης: 23/2/2024
[13]. Κάτοπτρον,ΒιογραφίαΛογίου/ΚούμαςΚωνσταντίνος:
Ημερομηνία προσπέλασης: 29/5/2024
Βιβλιογραφικές Αναφορές
Βιογραφικό συγγραφέως
[4]. Zacharia, Z., & Anderson, O. R. (2003). The effects of an interac
t
ive
computer-based simula
t
ion prior to performing a laboratory inquiry-
based experiment on students’ conceptual understanding of physics.
AmericanJournalofPhysics,71(6),
Ο Νίκος Αναστασάκης είναι πτυχιούχος του
τμήματος Φυσικής του ΕΚΠΑ και κάτοχος
μεταπτυχιακούδιπλώματοςστην«εξ
αποστάσεως εκπαίδευση με χρήση των
ΤΠΕ» του Πανεπιστημίου Κρήτης. Από το
2004 εργάζεται ως Φυσικός στη Δημόσια
Εκπαίδευση, και από το 2007 συνεργάζεται με το Ε.Κ.Φ.Ε.
Χανίων, του οποίου είναιυπεύθυνος από το 2017. Έχει
παρουσιάσει εργασίες σε συνέδρια Φυσικής αλλά και
εφαρμογής των ΤΠΕ, έχει δημοσιεύσει άρθρα σε σχετικά
περιοδικάκαιέχεισυμμετάσχειστηδημιουργία
εκπαιδευτικού υλικού σε έντυπη και ψηφιακή μορφή. Ως
επιμορφωτής συμμετέχει σε δράσεις και προγράμματα
618–629.
επιμόρφωσης μέσω του Ε.Κ.Φ.Ε. Χανίων, της ΠΑΝ.Ε.Κ.Φ.Ε.,
της ΠΔΕ Κρήτης, του ΙΕΠ και του ΙΤΥΕ Διόφαντος (Β’ επίπεδο).
Είναι μέλος του ΔΣ της ΠΑΝ.Ε.Κ.Φ.Ε. ως γραμματέας. Από το
2019 το εκπαιδευτικό ενδιαφέρον του επικεντρώνεται σε
μεθόδους ενσωμάτωσης της εργαστηριακής μεθόδου στην
διδασκαλία της Φυσικής για την δευτεροβάθμια και
πρωτοβάθμια εκπαίδευση.
8
Τεύχος 1
,
Ιούλιος 2024
Τεύχος 1
,
Ιούλιος 2024
Ηλεκτρο
φ
όρος
:
μ
ι
α
σύντομη
επ
ι
σ
κ
όπηση
Ευάγγελος Βάρθης
Συνεργάτης ΠΕ04.01 Ε.Κ.Φ.Ε. Κέρκυρας
Λέ
ξ
ε
ι
ς
Κ
λε
ι
δ
ι
ά
:
ηλε
κ
τρο
φ
όρος
,
στατ
ικ
ός
ηλε
κ
τρ
ι
σμός
,
μη
χ
ανή
W
i
ms
hur
s
t
Περ
ί
λη
ψ
η
Σ
ε
αυτό
το
άρ
θ
ρο
παρουσ
ι
ά
ζ
οντα
ι κ
άπο
ι
α
ενδε
ικ
τ
ικ
ά
πε
ι
ράματα
ηλε
κ
τροστατ
ικ
ής
φ
ύσε
ω
ς
,
συνοδευόμενα
όπου
ε
ί
να
ι
ε
φ
ικ
τό
με
μ
ικ
ροσ
κ
οπ
ικ
ές
ερμηνε
ί
ες
. Τ
α
πε
ι
ράματα
β
ασ
ίζ
οντα
ι
στην
κ
ατασ
κ
ευή
κ
α
ι χ
ρήση
του
ηλε
κ
τρο
φ
όρου
,
μ
ι
α
ς
στο
ιχ
ε
ιώ
δ
ου
ς
ηλε
κ
τροστατ
ικ
ή
ς κ
ατασ
κ
ευή
ς
η
οπο
ί
α
συ
χ
νά
παραμελε
ί
τα
ι
στη
δ
ι
δασ
κ
αλ
ί
α
του
ηλε
κ
τρ
ι
σμού
. Τ
α
πε
ι
ράματα
με
β
άση
τον
ηλε
κ
τρο
φ
όρο
ε
ί
να
ι
α
κί
νδυνα
κ
α
ι
εύ
κ
ολο
να
γ
ί
νουν
τόσο
στην
τά
ξ
η
αλλά
κ
α
ι
να
αναπαρα
χθ
ούν
από
τους
μα
θ
ητές
στο
σπ
ί
τ
ι
τους
.
Ο
ι
μα
θ
ητές
μπορούν
να
έ
χ
ουν
άμεση
εμπε
ι
ρ
ί
α
με
τα
στατ
ικ
ά
φ
ορτ
ί
α
που
δημ
ι
ουργούντα
ι
στ
ι
ς
δ
ι
ά
φ
ορες
περ
ι
πτ
ώ
σε
ι
ς
,
γεγονός
που
ε
ξ
άπτε
ι
την
περ
ι
έργε
ι
α
τ
ω
ν
μα
θ
ητ
ώ
ν
,
συμ
β
άλλε
ι
στην
κ
αλύτερη
κ
ατανόηση
τ
ω
ν
εννο
ιώ
ν
κ
α
ι
εμπλουτ
ίζ
ε
ι
ευ
χ
άρ
ι
στα
τη
δ
ι
δασ
κ
αλ
ί
α
.
Φυσική
εξισώσεις του Maxwell που ενοποιούσαν το έργο των
προηγούμενων ερευνητών και έθεσαν πλέον ισχυρά τα
θεμέλια του ηλεκτρομαγνητισμού. Αξίζει να σημειωθεί,
ότι ο Maxwell δεν γνώριζε σε βάθος τι οντότητα ακριβώς
αντιπροσώπευε η έννοια «φορτίο». Μόλις στα τέλη του
19ου αιώνα εισήχθη η έννοια του ηλεκτρονίου
(ανακάλυψη από J.J. Thomson, 1897) και κατά τις αρχές
του 20
ου
, του πρωτονίου (ανακάλυψη από Rutherford,
1909), ως φορείς του αρνητικού και θετικού φορτίου
αντίστοιχα. Το νετρόνιο ως ουδέτερο σωματίδιο
ανακαλύφθηκε από τον Chadwick το 1932.
Σχόλια για το άρθρο:
Το παρόν άρθροεστιάζει στα στατικά ηλεκτρικά
φορτία που μπορούν να παρατηρηθούν μετά την τριβή
μεταξύ διαφορετικών υλικών και εξετάζει τρόπους
ηλέκτρισηςχρησιμοποιώνταςτηνηλεκτροστατική
διάταξη του ηλεκτροφόρου Εικόνα 2.
Εικόνα 1. Μηχανή Wimshurst
Εισαγωγή
ηλεκτροστατικών φορτίων στην επιφάνεια του αγωγού.
Τα ηλεκτροστατικά φαινόμενα έγιναν αντιληπτά στην
αρχαία Ελλάδακαισυγκεκριμένα οπρώτος γιατονοποίο
έχουμε γραπτά τεκμήρια είναι ο Θαλής ο Μηλίσιος το
600 π.Χ. Ο Θαλής πειραματίστηκε με το «ήλεκτρον»,
δηλαδή το γνωστό μας κεχριμπάρι (το οποιο είναι
απολιθωμένο ρετσίνι πεύκου) και παρατήρησε ότι όταν
αυτό τριφτεί με μετάξι ή μαλλί, έλκει μικρά κομμάτια
χνούδι, άχυρο, ξερά φύλλα
1
κτλ. Τα ηλεκτρικά
φαινόμενα μελετηθήκαν σε μια πιο επιστημονική βάση
και πιο εντατικά από τα μέσα του 17
ου
αιώνα [1], όπου
ανακαλυφθήκαν τα δυο είδη ηλεκτρικού φορτίου. Στην
συνέχεια, ο Charles-Augus
t
in Coulomb το 1785, βρήκε
την σχέση που εκφράζει την δύναμη που ασκείται
μεταξύ φορτίων, ενώ κατά την διάρκεια του 19
ου
αιώνα,
υπήρξαν δημοσιεύσεις εργασιών όπου διεξαγόταν
λεπτομερής ανάλυση των ηλεκτρικών φαινόμενων,
όπως οι εργασίες του Oersted, Ampere και Faraday.
Ειδικότερα την περίοδο 1861-1862 διατυπωθήκαν οι
Η
διδασκαλία των ηλεκτροστατικών φαινομένων
αποτελεί το υπόβαθρο για την κατανόηση των
ηλεκτρομαγνητικών πεδίων και δυνάμεων που
δημιουργούνται γύρω μας και τα οποία σε γενικές
γραμμές είναι «αόρατα» αλλά συμμετέχουν σε κάθε
τεχνολογικήέκφρασητου σύγχρονου πολιτισμού. Ακόμα
και η κίνηση του ηλεκτρικού ρεύματος σε κύκλωμα
Εικόνα 2. Ο ηλεκτροφόρος πάνω στο πλεξιγκλάς
μπαταρίας συντελείται μέσω της κατανομής των
10
Τεύχος 1
,
Ιούλιος 2024
Στο άρθρο θα παρουσιαστούν επιλεγμένα πειράματα τα
όποια μπορούν να εκτελεστούν μετωπικά από τους
μαθητές αλλά και σε μορφή επίδειξης από τον καθηγητή
μέσα στην τάξη.
Για το υπόλοιπο του άρθρου, χωρίς να αναφέρεται, θα
θεωρείται ότι:
•
Τα υλικά στην Εικόνα 3 είναι ταξινομημένα από
πάνω προς τα κάτω, από το ηλεκτροθετικότερο προς
το ηλεκτραρνητικότερο. Το υλικό Α που βρίσκεται
πιο κοντά στην κορυφή θα φορτίζεται θετικά όταν
τρίβεταιμεκάποιουλικόΒπουβρίσκεται
χαμηλότερα στη λίστα, ενώ ταυτόχρονα το υλικό Β
θα φορτίζεται αρνητικά.
•
To Plexiglas φορτίζεται θετικά με τριβή χαρτιού,
βλέπε Εικόνα 3 και Εικόνα 4.
•
Το PVC φορτίζεται αρνητικά με τριβή χαρτιού, βλέπε
Εικόνα 3.
•
Όπου στις εικόνες δείχνεται ροή θετικού φορτιού,
αυτό ισοδυναμεί με κίνηση ηλεκτρόνιων προς την
αντίθετη φορά.
Περιγραφή ηλεκτροφόρου
Ο ηλεκτροφόρος αποτελεί μια απλή ηλεκτροστατική
διάταξη, Εικόνα 2, που μπορεί εύκολα να κατασκευαστεί
από μαθητές και αποτελεί το ουσιαστικό θεωρητικό και
πρακτικό υπόβαθρο για την λειτουργία της μηχανής
Wimshurst Εικόνα 1, αλλά και άλλων ηλεκτροστατικών
μηχανώνπου αναπτύχθηκανόπως π.χ.απότουςWilhelm
Holtz (1865 και 1867), August Toepler (1865), J. Robert
Voss (1880) και άλλους [2], [5].
Εικόνα 3. Λίστα υλικών για παραγωγή τρίβο-
ηλεκτρισμού ταξινομημένα από τα ηλεκτρο-
θετικότερα προς τα ηλεκτραρνητικότερα.
Εικόνα 4. Φόρτιση του ηλεκτροφόρου
Ηλεκτροθετικά
Πλεξιγκλάς
Βακελίτης
Νιτρική κυτταρίνη
Γυαλί
Χαλαζίας
Νάιλον
Μαλλί
Μετάξι
Βαμβάκι
Χαρτί
Κεχριμπάρι
Ρητίνες (φυσικές και τεχνητές)
Μέταλλα
Καουτσούκ
Οξικό ρεγιόν
Ντακρόν
Όριoν
Πολυστυρένιο
Τεφλόν
Πολυβινυλοχλωρίδιο (PVC)
Ηλεκτραρνητικά
11
Τεύχος 1
,
Ιούλιος 2024
Σημείωση:
Ο αέρας περιέχει ιόντα, κατά συνέπεια είναι
δυνατό να διαρρέεται ρεύμα μεταξύ υλικών που
βρίσκονται σε απόσταση και έχουν την
κατάλληλη διαφορά δυναμικού. Ο αέρας γίνεται
αγώγιμος μεταξύ υλικών όταν η τάση αποκτά
τιμή μεγαλύτερη από 3
⋅
10
6
Volt/m ή
3
⋅
10
4
Volt/cm. Υλικό σχετικό με την ηλεκτρική
εκκένωση του αέρα και ενδιαφέροντα πειράματα
μπορεί να βρεθούν στη μελέτη [6]. Αξίζει να
τονιστεί ότι στις φορτισμένες ακίδες, γύρω από
την περιοχή τους το ηλεκτρικό πεδίο καθίσταται
πιο έντονο (μεγαλύτερη πυκνότητα δυναμικών
γραμμών), Εικόνα 9δ. Επίσης βλέπε
Παράρτημα 3
για μια βαθύτερη μαθηματική και
φυσική κατανόηση του φαινομένου
2
.
Ηλεκτροφόρος ως δομικό υλικό για την Μηχανή
Wimshurst
Ειδικάγια
ηλεκτροστατικής
θεωρήσουμε τον κάθε τομέα του δίσκου Α ως ένα μικρό
ηλεκτροφόρο, που φορτίζεται επαγωγικά από τον
απέναντι τομέα του δίσκου Β συνιστώντας οι δυο τομείς
έναν πυκνωτή [1], Εικόνα 1.
-Οι τομείς κινούνται με τέτοιο τρόπο ώστε να
παρουσιάζεται επαγωγικός πολλαπλασιασμός του
φορτίουστουςπυκνωτέςπουστιγμιαία
δημιουργούνται (εξήγηση Παράρτημα 1).
-Σε κάθε δημιουργημένο αντικριστό ζεύγος τομέων
(πυκνωτή) οι πλάκες του απομακρύνονται καθώς
γυρίζει η μηχανή, η διαφορά δυναμικού μεταξύ των
τομέων αυξάνει (εξήγηση Παράρτημα 2.) και το
φορτίο συλλέγεται από τις βούρτσες.
-Το φορτίο των τομέων, λόγω υψηλού δυναμικού,
Φύλλο εργασίας ηλεκτροφόρου
Κατασκευή του ηλεκτροφόρου
Για την κατασκευή του ηλεκτροφόρου χρησιμοποιούμε
απλά υλικά όπως:
τηνπερίπτωσητηςγνωστής
μηχανής Wimshurst, μπορούμε να
•
αλουμινένιο πιάτο
•
πλαστικό ποτήρι
•
μονωτική ταινία
Κολλάμε το πλαστικό ποτήρι με την βοήθεια μονωτικής
ταινίας στο εσωτερικό (στο κέντρο) του αλουμινένιου
πιάτου και ο ηλεκτροφόρος είναι έτοιμος, Εικόνα 2.
Φόρτιση ηλεκτροφόρου
Η διαδικασία φόρτισης του ηλεκτροφόρου είναι η εξής:
•
Τρίβουμε φύλλο πλεξιγκλάς με χαρτί όποτε αυτό
φορτίζεται θετικά με βάση την Εικόνα 4.
συλλέγεται από τις βούρτσες της μηχανής μέσω του
•
Μια εκτεταμένη περιγραφή και ανάλυση διάφορων
ηλεκτροστατικών μηχανών και των κατασκευών τους
μπορεί να βρεθεί στο portal
του Antonio C. M. de Queiroz
επίσης στην μελέτη
του ιδίου [3].
•
Ακουμπάμε τον ηλεκτροφόρο πάνω στην επιφάνεια
του πλεξιγκλάς. Αυτό έχει ως συνέπεια τα θετικά
αέρα και αποθηκεύεται στα Leyden Jars (εξήγηση φορτία του πλεξιγκλάς να επάγουν στην κάτω
Παράρτημα 3.) πλευρά του ηλεκτροφόρου αρνητικό φορτίο ενώ
στην πάνω πλευρά θετικό, Εικόνα 4. Αξίζει να
Υλικό ανασκόπησης σχετικά με ηλεκτροστατικές σημειωθεί ότι ο ηλεκτροφόρος δεν μπορεί να
μηχανές και ηλεκτροστατικά φαινόμενα φορτιστεί μόνο με την επαφή του με το πλέξιγκλας
διότι το πλέξιγκλας είναι μονωτής και τα φορτία του
δεν μπορούν να μετακινηθούν.
•
Ακουμπάμε το δάκτυλο μας (λειτουργεί ως γείωση)
στον ηλεκτροφόρο ενώ αυτός είναι σε επαφή με το
πλεξιγκλάς. Τότε τα θετικά φόρτια εξουδετερώνονται
(ροή ηλεκτρονίων από την γείωση) και απομένουν
•
Μιααξιόλογηπαρουσίασητουιδίουτουμόνο τα πλεονάζοντα αρνητικά φόρτια της κάτω
κατασκευαστή της μηχανής Wimshurst, Jamesπλευράς, Εικόνα 4.
Wimshurst σχετικά με το ιστορικό και με τις αρχές
λειτουργίαςτωνηλεκτροστατικώνμηχανών
παρατίθεταιστο
.
Επίσης μια μονογραφία σχετικά με τον στατικό
ηλεκτρισμό από τους Giinter Liittgens, Sylvia Liittgens,
and Wolfgang Schubert [4], παρατίθεται στο
Εικόνα 5. α) Εκκένωση φορτισμένου ηλεκτροφόρου,
β) ταλάντωση από μπάλες κατασκευασμένες από
αλουμινόχαρτο μεταξύ φορτισμένου ηλεκτροφόρου
και γείωσης
12
Τεύχος 1
,
Ιούλιος 2024
Πειράματα με φορτισμένο ηλεκτροφόρο
Ηλεκτρική εκκένωση με το δάχτυλο
Εάν πλησιάσουμε το δάχτυλο μας κοντά στον
φορτισμένο ηλεκτροφόρο, τότε θα παρατηρήσουμε ότι
περίπου σε μια απόσταση 0.5- 1 cm θα γίνει εκκένωση
του ηλεκτρικού φορτίου στο δάχτυλο μας, Εικόνα 5α.
Ταλάντωση αγώγιμων σφαιρών πάνω σε
φορτισμένο ηλεκτροφόρο
Τοποθετούμε τον ηλεκτροφόρο κάθετα και μέσα σε
ένα μικρό πλαστικό κύλινδρο, αγώγιμο στις βάσεις του,
βάζουμεδυο-τρειςελαφριέςαγώγιμεςσφαίρες
(αλουμινόχαρτο), Εικόνα 5β. Ακουμπώντας την μια βάση
του κυλίνδρου στον ηλεκτροφόρο και την άλλη στο
δάκτυλο μας θα παρατηρήσουμε ότι οι σφαίρες
ταλαντώνονται.Η εξήγηση παρουσιάζεταιστην
παρακάτω Εικόνα 6β. Η πρώτη σφαίρα μετατρέπεται σε
δίπολα λόγω επαγωγικής ηλέκτρισης όποτε έλκεται από
εκκένωση.
•
Σηκώνουμε τον ηλεκτροφόρο, τώρα αυτός είναι
τοναρνητικάφ
ο
ρτισμένοηλεκτροφ
ό
ρο.Ο
φορτισμένος αρνητικά με δυναμικό που η τιμή του
ηλεκτροφ
ό
ρος εξουδετερώνει το θετικό φ
ο
ρτίο και
η
είναι της τάξεως 2-3 χιλιάδων Volt [7], αλλά εντελώςσφαίραλόγω επαφήςφορτίζεταιαρνητικά και
ακίνδυνο διότι η ποσότητα ηλεκτρικού ρεύματος
απωθείται,ενώ ταυτόχρ
ο
να μέρος τ
ο
υφ
ο
ρτίου
είναι πολύ περιορισμένη κατά την ηλεκτρική
μεταφέρεται
σ
τις υπόλοιπες σφαίρες. Στην άλλη
μ
εριά
αποβάλλεται το αρνητικό φορτίο από τις τελευταίες
σφαίρες στη γείωση (το χέρι μας) και το φαινόμενο
επαναλαμβάνεται [6].
Ταλάντωση μπίλιας μεταξύ δυο ηλεκτροφόρων
με αντίθετα φορτία
Το φαινόμενο είναι παρόμοιο με το προηγούμενο.
Έχουμε δυο ηλεκτροφόρους με αντίθετα φορτία όπου ο
ένας έχει φορτιστεί με πλεξιγκλάς ενώ ο άλλο με PVC και
βρίσκονται σε απόσταση 5-10 cm, Εικόνα 6α. Στην μέση
κρεμάμε με κλώστηαγώγιμηελαφριά σφαίρα(σφαιρίδιο
από αλουμινόχαρτο) και παρατηρούμε ότι η σφαίρα
ταλαντώνεται μεταξύ των ηλεκτροφόρων. Η εξήγηση με
βάση την Εικόνα 6β, είναι ότι τώρα στην σφαίρα
δημιουργείται ένα πιο ισχυρό δίπολο λόγω επαγωγής και
από τους δυο ηλεκτροφόρους. Έστω ότι η σφαίρα
έλκεταιστηναρνητικήπλάκαόποτετοδίπολο
εξαφανίζεται λόγω εξουδετέρωσης του θετικού φορτίου.
Στην συνέχεια η σφαίρα φορτίζεται αρνητικά όποτε και
απωθείται προς τον θετικά φορτισμένο ηλεκτροφόρο και
Εικόνα 6. α) Ταλάντωση μπίλιας μεταξύ δυο αντίθετα φορτισμένων ηλεκτροφόρων, β) επαγωγική εξήγηση
φαινομένου σε χρονικές στιγμές t1 < t2 < t3.
13
Τεύχος 1
,
Ιούλιος 2024
2016).
Φόρτιση ηλεκτροσκοπίου.
παρατηρήσουμε την απόκλιση του ηλεκτροσκοπίου,
Εικόνα 7α.
Με επαφή
Στηνπερίπτωσηαυτήακουμπάμεαπλάτον
ηλεκτροφόρο πάνω στο ηλεκτροσκόπιο. Μπορούμε να
επαναλάβουμετηνφόρτιση μεεπαφή2-3φόρες.Τότεθα
παρατηρήσουμε ότι τα φύλλα του ηλεκτροσκοπίου θα
το φαινόμενο επαναλαμβάνεται, (Ivanov and Nikolovαποκλίνουνπερισσότεροσεκάθεεκκένωσητου
ηλεκτροφόρου, αφού το επιπλέον φορτίο ρέει προς το
ηλεκτροσκόπιο. Η ηλέκτριση θα σταματήσει όταν το
ηλεκτροσκόπιο θα αποκτήσει το ίδιο δυναμικό με τον
φορτισμένο ηλεκτροφόρο, Εικόνα 7β.
Αύξηση διαφοράς δυναμικού στην
απομάκρυνση πλακών πυκνωτή
Εάν πλησιάσουμε τον φορτισμένο ηλεκτροφόρο σε
ένα κλασικό ηλεκτροσκόπιο τότε αυτό θα ηλεκτριστεί (τα
ελάσματα του ηλεκτροσκοπίου θα αποκλίνουν) με δυο
τρόπους:
Με επαγωγή
Θα απαιτηθεί:
Απλά πλησιάζουμε τον ηλεκτροφόρο κοντά στο
εκκένωση του φορτιού μέσω του αέρα. Εναλλακτικά για
ευκολία μπορούμε να βάλουμε μια λεπτή αφόρτιστη
διηλεκτρική επιφάνεια π.χ. πλαστικό, πλεξιγκλάς, PVC
κτλ. πάνω στην επιφάνεια του ηλεκτροσκοπίου και να
ακουμπήσουμε πάνω σε αυτό τον ηλεκτροφόρο ώστε
ηλεκτροσκόπιο προσέχ
ο
ντας ώ
σ
τε να μην υπάρξει
•
Ηλεκτροσκόπιο
•
Μικρό κομμάτι Πλεξιγκλάς
•
Ηλεκτροφόρος
Συνδέουμε τα υλικά όπως δείχνεται στην Εικόνα 8.
•
Τοποθετούμε το πλέξιγκλας πάνω στην βάση του
ηλεκτροσκοπίου.
•
Τοποθετούμε τον φορτισμένο ηλεκτροφόρο πάνω
στοπλέξιγκλας.Θαπαρατηρήσουμεότιτο
ηλεκτροσκόπιο αποκλίνει. Ακουμπάμε στιγμιαία το
δάχτυλο μας στην κάτω μεριά της πλάκας του
Εικόνα 7. α) Φόρτιση με επαγωγή και κατανομή φορτίων σε ηλεκτροσκόπιο, β) φόρτιση με απλή επαφή και
κατανομή φορτίων.
14
Τεύχος 1
,
Ιούλιος 2024
ηλεκτροσκόπιο δεν είναι πλέον ηλεκτρισμένο.
•
Απομακρύνουμε τον ηλεκτροφόρο και παρατηρούμε
ότι το ηλεκτροσκόπιο πάλι αποκλίνει.
Εξήγηση
Το φαινόμενο είναι γνωστό για την περίπτωση ενός
φορτισμένου πυκνωτή όταν απομακρύνουμε τις πλάκες
του. Παρατηρείται ότι όταν αυξάνεται η απόσταση,
αυξάνεται η διαφορά δυναμικού ενώ η χωρητικότητα
μειώνεται κατά τέτοιο τρόπο, ώστε το φορτίο να
παραμένει σταθερό (Παράρτημα 1). Η πάνω επιφάνεια
του ηλεκτροσκοπίου, το πλεξιγκλάς ως διηλεκτρικό και ο
ηλεκτροφόρος συνιστούν στην ουσία έναν πυκνωτή στην
Εικόνα 8β και Εικόνα 8γ. Κατά συνέπεια, η απομάκρυνση
του ηλεκτροφόρου αυξάνει την διαφορά δυναμικού
μεταξύ της επιφάνειας του ηλεκτροσκοπίου και του
ηλεκτροφόρου και τα φύλλα αποκλίνουν.
Παραρτήματα
Παράρτημα 1.
Αύξηση φορτίου με επαγωγή
Στην Εικόνα 9γ παρουσιάζεται ο τρόπος συνεχούς
αύξησης φορτίου με επαγωγή που συμβαίνει για τον
πολλαπλασιασμό του φορτίου στην μηχανή Wimshurst.
Καθώς οι δίσκοι στην μηχανή Wimshurst περιστρέφονται
με αντίθετη φορά, οι διαμετρικοί τομείς στον ίδιο δίσκο,
ηλεκτροσκοπίου.Θαπαρατηρήσουμεότιτοενώνονται στιγμιαία με την βοήθεια των ράβδων
"γείωσης" σε συγκεκριμένες θέσεις. Την στιγμή που οι
τομείς συνδέονται με τη ράβδο "γείωσης", αυτοί αρχικά
φορτίζονται επαγωγικά από το φορτίο του απέναντι
τομέα του δίσκου όπως δείχνει η Εικόνα 9γ.
Το φορτίο ωστόσο στον κάθε τομέα αυξάνει με κάθε
κύκλο της περιστροφής. Αυτό συμβαίνει διότι όταν
φορτιστούν όλοι οι τομείς με φορτίο έστω Q,στην
συνέχεια στην επαγωγική φόρτιση συμμετέχουν και οι
διπλανοί τομείς επάγοντας έτσι ένα αυξημένο φορτίο
Q’>Q, Εικόνα 9ε.
Παράρτημα 2.
Αύξηση διαφοράς δυναμικού σε πυκνωτή
Έστω ότι έχουμε έναν πυκνωτή με χωρητικότητα C και
διαφορά δυναμικού μεταξύ των οπλισμών του V, τότε το
φορτίο θα είναι
𝑄 = C ∙ V
. Εάν απομακρύνουμε τους
οπλισμούς του πυκνωτή τότε μειώνεται η χωρητικότητα
𝑆𝑆
του από
𝐶 = 𝜀
𝜊
𝐿
σε
𝐶′ = 𝜀
𝜊
𝐿′
όπου L’>L και
ταυτόχρονα αυξάνεται η διαφορά δυναμικού σε V’ αφού
το φορτίο παραμένει το ίδιο
𝑄 = 𝐶′ ∙ 𝑉′
.
Η ενεργεία του πυκνωτή μεταβάλλεται από:
11
E =
2
C ∙ V
2
σε
E′ =
2
C′ ∙ V′
2
EV
κατά συνέπεια
E
′
=
V
′
< 1
δηλαδή
E′ > E
. Το Ε’
αυξάνεται διότι πρέπει να καταναλωθεί έργο για να
Εικόνα 8. α) Φόρτιση με επαγωγή, το ηλεκτροσκόπιο αποκλίνει, β) εφαρμογή γείωσης, το ηλεκτροσκόπιο από-
ηλεκτρίζεται, γ) το ηλεκτροσκόπιο αποκλίνει ξανά.
15
Τεύχος 1
,
Ιούλιος 2024
αυξάνει στην ουσία την δυναμική ενεργεία του πυκνωτή.
Παράρτημα 3.
Φαινόμενο ακίδας
Έστω ότι έχουμε μια σφαίρα Α ακτίνας R και μια
σφαίρα Β ακτίνας r, όπου
𝑅 > 𝑟
. Η σφαίρα Α έχει αρχικά
ηλεκτρικό φορτίο Q. Αν συνδέσουμε τις δυο σφαίρες Α
και Β με αγώγιμο σύρμα, τότε να εξετάσετε τι θα συμβεί
σε κάθε σφαίρα όταν αποκατασταθεί ηλεκτροστατική
ισορροπία (δηλαδή V
big
=V
small
) όσο αναφορά τα μεγέθη:
απομακρυνθούν οι πλάκες του πυκνωτή το οποίοα) δυναμικό, β) πυκνότητα ηλεκτρικού φορτίου, γ)
ηλεκτρικό πεδίο - δυναμικές γραμμές.
Ανάλυση:
Οι δυο σφαίρες με ακτίνες r και
𝑅 = 𝑛𝑟
αντίστοιχα,
στην ηλεκτροστατική ισορροπία θα αποκτήσουν το ίδιο
δυναμικό οπότε:
=→ 𝑞 =
𝑘
(𝑄−
𝑞
)
𝑘𝑞
𝑄
𝑛𝑟𝑟𝑛
+1
(1)
Εικόνα 9. α) αύξηση διαφοράς δυναμικού σε πυκνωτή, β) σφαίρες διαφορετικού μεγέθους, γ) επαγωγική
διαδικασία πολλαπλασιασμού φορτίου σε Wimshurst, δ) ισχυρότερο ηλεκτρικό πεδίο στο χώρο γύρω από ακίδα, ε)
επαγωγική διαδικασία πολλαπλασιασμού φορτίου από διπλανούς τομείς.
16
Τεύχος 1
,
Ιούλιος 2024
Οι επιφανειακές πυκνότητες φορτίου σ
Α
και σ
Β
κάνοντας
χρήση της εξίσωσης (1) απλοποιούνται και η μεταξύ τους
σχέση δίνεται παρακάτω:
Η μεγαλύτερη σφαίρα Α ( ακτίνας
𝑅 = 𝑛𝑟
) θα
κατακρατεί περισσότερο φορτίο αλλά θα έχει μικρότερη
επιφανειακή πυκνότητα φορτίου.
Κατά συνέπεια η μικρή σφαίρα Β ή αλλιώς η ακίδα,
επειδή έχει
φορτίου θα
μεγαλύτερη επιφανειακή
έχει πιο έντονο ηλεκτρικό
δυναμικές γραμμές θα είναι
πιο πυκνές), και τα
ηλεκτρικά φαινόμενα όπως η
εκκένωση ηλεκτρικού
Συμπεράσματα
μπορεί αφενός να τα εκτελέσει, αφετέρου να ελέγξει
φαινόμενα που δημιουργούνται μέσω σωματιδίων που
δεν βλέπει και να εξάγει συμπεράσματα.
Βιβλιογραφικές Αναφορές
[1]Panat, P. 2003. Contribu
t
ions of Maxwell to electromagne
t
ism. Resonance
8(5), pp. 17–29.,
[2]Gray, J. 1890. Electrical in
f
l
uence machines. Whittaker.,
[3]de Queiroz, A.C.M. 2019. Varia
t
ions of the doubler of electricity. Physics
Educa
t
ion 54(3), p. 035019.
[4]Lüttgens, G., Lüttgens, S. and Schubert, W. 2017. Sta
t
ic Electricity:
Understanding, Controlling, Applying. John Wiley & Sons.
[5]Aguilar, H.M. 2014. The Wimshurst machine as an electric circuit. Lat. Am.
J. Phys. Educ. Vol 8(1), p. 100.,
[6]Ivanov, D. and Nikolov, S. 2016. Electrosta
t
ics experiments with sharp metal
points. Physics Educa
t
ion 51(6), p. 065019.
[7]Burgo, T.A., Silva, C.A., Balestrin, L. and Galembeck, F. 2013. Fric
t
ion
coeficient dependence on electrosta
t
ic tribocharging. Scien
t
i
f
i
c reports
3(1), pp. 1–8.
πυκνότητα
Σημειώσεις
πεδίο (οι
1)
2)
Ευχαριστίες
Σε αυτό το άρθρο παρουσιαστήκαν μια σειρά από
απλά πειράματα, στηριζόμενα στον ηλεκτροφόρο, τα
οποία μπορούν να διεξαχθούν εύκολα από τους μαθητές
προς καλύτερη κατανόηση του στατικού ηλεκτρισμού και
εν γένει των ηλεκτρικών κατά βάση φαινομένων. Έγινε
προσπάθεια να δοθούν όπου ήταν εφικτό, ερμηνείες
σχετικά με τα ηλεκτροστατικά φαινόμενα για περαιτέρω
εμβάθυνση. Τα παρουσιαζόμενα πειράματα κάνουν την
διδασκαλία των ηλεκτροστατικών φαινομένων πιο
ευχάριστη και δίνουν ικανοποίηση στον μαθητή διότι
Θα ήταν αγνωμοσύνη να μην απευθύνω ευχαριστίες
στον αγαπητό συνάδελφο και «δάσκαλο» μου στα
πειραματικά φαινόμενα και τις πειραματικές κατασκευές
Παναγιώτη Μουρούζη. Η εκτενής συζήτηση και οι
πειραματικές επαληθεύσεις που πραγματοποιήσαμε σε
ευρύφάσμαηλεκτροστατικώνφαινόμενωνκαι
ειδικότερα για την κατανόηση λειτουργίας της μηχανής
Wilmshurst είναι ανεκτίμητη. Χωρίς την βοήθεια του το
άρθρο αυτό δεν θα είχε πραγματοποιηθεί, από καρδιάς
τον ευχαριστώ.
𝜎
Α
=
𝑘(𝑄 − 𝑞)
4𝜋𝑛
2
𝜎
𝛣
=
4𝜋𝑟
2
𝑘(𝑞)
𝑟
2
} → 𝜎
𝛣
= 𝑛𝜎
𝐴
φορτίου μέσω του αέρα θα είναι πιο έντονα.
Βιογραφικό συγγραφέως
Ο Ευάγγελος Βάρθης είναι πρώην συνεργάτης
στο Ε.Κ.Φ.Ε. Κέρκυρας, σπούδασε Φυσική στο
ΠανεπιστήμιοΙωάννινων,καιεκπόνησε
Διδακτορική Διατριβή στη Σχολή Επιστήμης
της Πληροφορίας και Πληροφορικής του
Ιόνιου Πανεπιστήμιου. Τα ερευνητικά του ενδιαφέροντα είναι
η πειραματική φυσική, αλγόριθμοι, προγραμματισμός και
μέθοδοι διασύνδεσης πληροφορίας.
17
Τεύχος 1
,
Ιούλιος 2024
Μ
ε
π
ε
ι
ρ
ά
μ
α
τ
α
ηλε
κ
τρ
ι
σμού
α
ν
α
κ
α
λύ
π
τουμε
τη
δομή
της
ύλης
:
μ
ι
α
δ
ι
α
θ
εματ
ικ
ή
δ
ι
δα
κ
τ
ικ
ή
πρόταση
Περ
ί
λη
ψ
η
Λέ
ξ
ε
ι
ς
Κ
λε
ι
δ
ι
ά
:
Δομ
ικ
ά
σ
ω
ματ
ί
δ
ι
α
, χ
ημ
ικ
ός
δεσμός
,
αγ
ω
γ
ι
μότητα
,
παρανοήσε
ι
ς
Σ
τη
δ
ι
δα
κ
τ
ικ
ή
αυτή
πρόταση
ο
ι
μα
θ
ητές
/
τρ
ι
ες
θ
α
ταυτοπο
ι
ήσουν
το
ε
ί
δος
τ
ω
ν
δομ
ικώ
ν
σ
ω
ματ
ι
δ
ίω
ν
κ
α
ι
τον
χ
ημ
ικ
ό
δεσμό
,
με
τον
οπο
ί
ο
συνδέοντα
ι
αυτά
,
σε
συγ
κ
ε
κ
ρ
ι
μένα
υλ
ικ
ά
.
Η
ταυτοπο
ί
ηση
γ
ί
νετα
ι
μέσα
από
πε
ι
ραματ
ικ
ές
δραστηρ
ι
ότητες
,
που
σ
χ
ετ
ίζ
οντα
ι
με
το
κ
ε
φ
άλα
ι
ο
του
ηλε
κ
τρ
ι
σμού
.
Γ
ι
α
τον
σ
κ
οπό
αυτό
ο
ι
μα
θ
ητές
κ
ατασ
κ
ευά
ζ
ουν
ένα
ηλε
κ
τρ
ικ
ό
κ
ύ
κ
λ
ω
μα
από
τα
«
στο
ιχ
ε
ί
α
»
του
,
τα
ξ
ι
νομούν
υλ
ικ
ά
σε
αγ
ω
γούς
κ
α
ι
μον
ω
τές
κ
α
ι κ
ατόπ
ι
ν
παρασ
κ
ευά
ζ
ουν
δ
ι
αλύματα
τρ
ιώ
ν
ουσ
ιώ
ν
κ
α
ι
ελέγ
χ
ουν
την
αγ
ω
γ
ι
μότητά
τους
. Σ
το
τέλος
ερμηνεύουν
τα
πε
ι
ραματ
ικ
ά
αποτελέσματα
κ
α
ι
μέσα
απόανα
κ
ατασ
κ
ευασμένα
κ
ε
ί
μενα
β
ρ
ί
σ
κ
ουν
,
σε
κ
ά
θ
ε
περ
ί
πτ
ω
ση
,
τους
φ
ορε
ί
ς
του
ηλε
κ
τρ
ικ
ού
ρεύματος
, κ
α
θώ
ς
κ
α
ι
το
ε
ί
δος
του
χ
Χημεία
Αγαθονίκη Μαμζερίδου
Τέως συνεργάτιδα Ε.Κ.Φ.Ε. Κέντρου
niki.mamzeridou@gmail.com
Αναστασία Γκιγκούδη
Υπεύθυνη Ε.Κ.Φ.Ε. Τούμπας
Τεύχος 1, Ιούλιος 2024
μία παρατήρηση ενός φαινομένου και κατόπιν αυτά
ερμηνεύονται με βάση κάποια θεωρία ή άλλες
επιστημονικές ανακαλύψεις [3].
Κι ενώ στα μαθήματα του Γυμνασίου προηγείται το
πείραμα και η παρατήρηση δηλαδή οι μακροσκοπικές
παρατηρήσεις, στη Χημεία της Α’ Λυκείου πρώτα δίνεται
έναςορισμόςγιατοχημικόδεσμό, κατόπιν ο
σχηματισμός του προσεγγίζεται με τον κανόνα των οκτώ
και στο τέλος αναφέρονται οι ιδιότητες των ενώσεων
που προκύπτουν [4].
Η διδασκαλία με έμφαση στον τρόπο δημιουργίας των
δύο ειδών δεσμών (ιοντικός-ομοιοπολικός) με
συμπλήρωση της οκτάδας των ηλεκτρονίων οδηγεί
Εισαγωγή
ι μαθητές/τριες του Γυμνασίου διδάσκονται για
τα δομικά σωματίδια της ύλης και τον τρόπο
πουαυτάσυνδέονταιμεταξύτουςστα
μαθήματα των Φυσικών Επιστημών. Συγκεκριμένα στο
μάθημα Χημείας της Β’ Τάξης οι μαθητές/τριες μετά από
μακροσκοπικέςπαρατηρήσειςκαταλήγουνστο
συμπέρασμα ότι οι χημικές ενώσεις αποτελούνται από
απλούστερες ουσίες τα “χημικά στοιχεία” που δεν
διασπώνται.
Σύμφωνα με την ατομική θεωρία που διδάσκονται
μετά την διενέργεια των πειραμάτων μαθαίνουν ότι όλες
οι ουσίες αποτελούνται από άτομα που ενώνονται
μεταξύ τους και σχηματίζουν μόρια.
Ο
μπορούν να δουν τη διαφορά απλού-διπλού δεσμού.
Σχεδόν σε όλες τις ενότητες, πρώτα γίνεται ένα πείραμα,
Εικόνα 2. Κατασκευή και έλεγχος λειτουργίας ηλεκτρικού
κυκλώματος.
Μετά την αναφορά ιστορικών περαμάτων (Curie,
Rutherford)εισάγονταιστηνυποατομικήδομή,
διδάσκεται ο υποατομικός τρόπος σχηματισμού ιόντων
και πειραματικά αποδεικνύεται ότι ορισμένα υλικά
βρίσκονται στα διαλύματά τους σε μορφή ιόντων [1].
Στο μάθημα της Φυσικής της Γ’ Γυμνασίου οι
μαθητές/τριες εισάγονται με απλές πειραματικές
δραστηριότητες στην έννοια του ηλεκτρικού φορτίου
και, μέσα από αναφορές σε ιστορικά πειράματα, στην
υποατομική δομή. Κατόπιν τούτου, μπορούν να
ερμηνεύσουν τη φόρτιση των σωμάτων με διάφορους
τρόπους με την μετακίνηση των ηλεκτρονίων. Με βάση
την υποατομική δομή των μετάλλων μπορούν να
εξηγήσουν την αγωγιμότητά τους και έτσι εισάγονται
στην έννοια του ηλεκτρικού ρεύματος [2].
Εικόνα 1. Υλικά για τις πειραματικές δραστηριότητες.
Στη Χημεία της Γ’ Γυμνασίου οι μαθητές/τριες
διαπιστώνουν τις ιδιότητες των οξέων (μακροσκοπικό
επίπεδο) και οι οποίες ερμηνεύονται με τη θεωρία του
Arrhenius (μικροσκοπικό επίπεδο). Το ίδιο γίνεται και
στις βάσεις.Στη διδακτική ενότητα του Περιοδικού
Πίνακα οι μαθητές/τριες για πρώτη φορά εμβαθύνουν
στη δομή του ατόμου, την κατανομή των ηλεκτρονίωνσε
στιβάδες και κατανοούν ότι οι ιδιότητες των χημικών
στοιχείων εξαρτώνται από τον αριθμό των ηλεκτρονίων
της τελευταίας στιβάδας. Στον άνθρακα οι διαφορές στις
φυσικές ιδιότητες των διαφορετικών μορφών του
(διαμάντι, γραφίτης) εντοπίζονται και εξηγούνται από
τον διαφορετικό τρόπο πουσυνδέονται τα άτομα μεταξύ
τους.Στους υδρογονάνθρακεςγιαπρώτηφορά
εμφανίζεται η λέξη «δεσμός» και, μόνο συμβολικά,
19
Διδακτική πρόταση
Ξεκινάτηδιδασκαλίααπότα
μέταλλα, συνεχίζει με τις ιοντικές
δομές, κατόπιν με τις γιγάντιες
ομοιοπολικές δομές και τέλος με τις
απλές μοριακέςδομές. Η
διδασκαλία και η εξήγηση των
δεσμώνσεόλες τις δομές στηρίζεται
σε ηλεκτροστατικές έλξεις [5]. Οι
Ray Lee και Maurice M. W. Cheng,
στηδιδακτικήτους πρόταση,
ξεκινούν τη διδασκαλία με τις
ιδιότητεςτων ουσιώνσε
μακροσκοπικόεπίπεδο. Στη
συνέχεια παρουσιάζονται οι δομές
σε υποατομικό επίπεδο και οι
ηλεκτροστατικές αλληλεπιδράσεις
μεταξύ των δομικών συστατικών για
να εξηγήσουν τις ιδιότητες. Η
κυρίαρχη ιδέα στη διδασκαλία είναι
οι ηλεκτροστατικές δυνάμεις και όχι
αυτόπουσυμβαίνεισταηλεκτρόνιαγιανα
σχηματιστούν οι δεσμοί (μεταφορά ηλεκτρονίων,
συνεισφορά ηλεκτρονίων ή ο σχηματισμός μιας
θάλασσας ηλεκτρονίων) [6].
Μεθοδολογία
Οι μαθητές/τριες, προκειμένου να ταυτοποιήσουν το
είδος των δομικών σωματιδίων και των χημικών δεσμών
που υφίστανται σε κατάλληλα επιλεγμένα στερεά υλικά
Εικόνα 1, πραγματοποιούνπειραματικέςδραστηριότητες
του ομοιοπολικού δεσμού
•
βλέπουν όλους τους δεσμούς να περιλαμβάνουν
διακριτά μόρια και δεν κατανοούν τη φύση του
ιοντικού και του μεταλλικού δεσμού καθώς και τις
«γιγάντιες» ομοιοπολικές δομές (γραφίτης, διαμάντι
κλπ.) [5].
τους/τις μαθητές/τριες σε λανθασμένες
ερμηνείεςκαιπαρανοήσεις.Έτσιοι
μαθητές/τριες
•
έχουνεσφαλμένοκαιακατάλληλο
σκεπτικό σχετικά με την αιτία που
δημιουργείται ο δεσμός
•
αγνοούν κάποιες περιπτώσεις δεσμού
αν δεν ταιριάζουν με την περιγραφή
“συνεισφοράηλεκτρονίων”ή
“μεταφορά ηλεκτρονίων”
•
δεν μπορούν να κατανοήσουν τα
ενδιάμεσα είδη δεσμών (πολωμένος
δεσμός) και συχνά λαμβάνουν υπόψη
Εικόνα 3. Εισαγωγική δραστηριότητα από το φύλλο εργασίας.
μόνο την περίπτωση του ιοντικού και
Η διδακτική πρόταση που προτείνεται στηρίζεται στις
απόψεις των Taber και Lee – Cheng. Ο Keith Taber
προτείνει μία συγκεκριμένη σειρά διδασκαλίας των
χημικών δεσμών σε στερεές δομές.
Εικόνα 4. Πρώτη πειραματική δραστηριότητα στο φύλλο εργασίας.
20
Τεύχος 1, Ιούλιος 2024
για να ελέγξουν αν υπάρχουν φορείς του ηλεκτρικού
ρεύματος.
Σε καθεμία από τις τρεις πρώτες φάσεις, ανιχνεύονται
οι αρχικές απόψεις των μαθητών/τριών, καταγράφονται
στο φύλλο εργασίας, γίνεται συζήτηση στην τάξη,
πραγματοποιείται η πειραματική δραστηριότητα και στο
τέλος κάθε φάσης καταγράφονται οι νέες απόψεις. Στην
επόμενηφάσηοιμαθητές/τριεςερμηνεύουντα
αποτελέσματα τωνπειραματικών δραστηριοτήτων,
στηριζόμενοι σε κατάλληλα διαμορφωμένα για την
περίπτωση επιστημονικά κείμενα.
κυκλώματος.
Μετάτιςπειραματικές
δραστηριότητες, γίνεταιη
ερμηνεία των αποτελεσμάτων,
Εικόνα 6, μέσα από
«ανακατασκευασμένα κείμενα»
καιοπτικές αναπαραστάσεις,
όπου περιγράφεται αυτό που
συμβαίνει σε κάθε δομή σε
υποατομικό επίπεδοκαι οι
ηλεκτροστατικές
αναπτύσσονται
δυνάμεις που
ανάμεσα στα
δομικά σωματίδια των υλικών.
Έτσι οι μαθητές/τριες μπορούν
να εξηγήσουν τη συμπεριφορά
των αγωγών, το είδος των
δομικών σωματιδίων από τα
οποία αποτελούνται τα αγώγιμα και τα μη αγώγιμα
υλικά, καθώς και τον χημικό δεσμό που υφίσταται στις
χημικές ενώσεις από την αγωγιμότητα των διαλυμάτων
τους.
Συμπεράσματα
Η διδακτική παρέμβασηπραγματοποιήθηκε σε
Λύκειο της περιοχής της Ανατολικής Θεσσαλονίκης σε
μαθητές της Α’ τάξης, πριν διδαχθούν τους χημικούς
δεσμούς.Είχεδιάρκεια δύοδιδακτικέςώρες,
ολοκληρώθηκε μέσα στον προβλεπόμενο χρόνο και οι
συμμετέχοντες έδειξαν ενδιαφέρον για όλες τις
δραστηριότητες. Σε κάθε δραστηριότητα, οι ομάδες
ακολουθούσαν τη δομή του φύλλου εργασίας. Από τα
συμπληρωμένα φύλλα εργασίας φάνηκε ότι οι αρχικές
Στην εισαγωγική δραστηριότητα Εικόνα 3, οι
μαθητές/τριες κάθε ομάδας ανακαλούν τις γνώσεις τους
για το ηλεκτρικό κύκλωμα και το ηλεκτρικό ρεύμα,
σχεδιάζουν τη συνδεσμολογία του με βάση τα διαθέσιμα
υλικά, κατασκευάζουν το «δικό» τους κύκλωμα και
ελέγχουν τη λειτουργία του, Εικόνα 2.
Στην πρώτη πειραματική δραστηριότητα Εικόνα 4, οι
μαθητές/τριεςταξινομούνεπτά στερεάυλικά σε
αγωγούς και μονωτές. Αρχικά προβλέπουν και κατόπιν,
κάνονταςχρήσητου ηλεκτρικούκυκλώματος,
επαληθεύουν ή απορρίπτουν την πρόβλεψή τους. Στο
τέλος της δραστηριότητας τους ζητείται να υποθέσουν
πού οφείλεται η αγωγιμότητα των υλικών.
Στηδεύτερηπειραματικήδραστηριότηταοι
μαθητές/τριες παρασκευάζουν διαλύματατριών
στερεών χημικών ενώσεων (μία ιοντική και δύο
ομοιοπολικές), Εικόνα 5 και ελέγχουν την αγωγιμότητά
τους απότην έντασητης
φωτοβολίας του λαμπτήρα του
Εικόνα 6. Ερμηνεία αποτελεσμάτων πειραματικών δραστηριοτήτων στο φύλλο
εργασίας.
Εικόνα 5. Παρασκευή διαλυμάτων και έλεγχος της
αγωγιμότητάς τους.
21
Τεύχος 1, Ιούλιος 2024
προβλέψεις των μαθητών/τριών αναθεωρήθηκαν από
τους ίδιους με βάση τα πειραματικά αποτελέσματα. Η
πρόβλεψή τους για τα υλικά που είναι αγωγοί είναι
διαφορετικήαπόαυτόπουδιαπιστώνουνστην
πειραματική δραστηριότητα. Ακόμη, διαπιστώθηκε η
δυσκολία που έχει ένα μικρό ποσοστό μαθητών να
κατανοήσει κείμενα με αφηρημένες έννοιες και να
ερμηνεύσει τα πραγματικά γεγονότα με βάση τα
κείμενα.
Μετάτηδιδακτικήπαρέμβασημοιράστηκαν
ερωτηματολόγιαμε ερωτήσειςσχετικέςμετο
αντικείμενο. Το ίδιο ερωτηματολόγιο μοιράστηκε στους
μαθητές ενόςτμήματοςτου σχολείου που
πραγματοποίησε την διδασκαλία με τον κλασσικό τρόπο
και χωρίς πειραματικές δραστηριότητες. Μια σύντομη
επεξεργασία των ερωτηματολογίων έδειξε ότι ο μέσος
όρος της βαθμολογίας ήταν καλύτερος στους μαθητές
που εφαρμόστηκε η παρέμβαση. Επιπλέον οι ερωτήσεις
στις οποίες απάντησε σωστά μεγαλύτερος αριθμός
μαθητών από αυτούς που εργάστηκαν πειραματικά σε
σχέση με το ποσοστό των μαθητών της κλασσικής
διδακτικής προσέγγισης είχαν σχέση με τις
μακροσκοπικές παρατηρήσεις.
Οι ερωτήσεις αυτές ήταν οι παρακάτω:
Συμπερασματικά, μπορούμε να πούμεότι η διδακτική
πρόταση για τη διδασκαλία της δομής της ύλης και των
χημικών δεσμών με χρήση πειραμάτων από το κεφάλαιο
του ηλεκτρισμού οδηγεί σε μεγαλύτερη κατανόηση
αυτών των εννοιών.
Βιβλιογραφικές Αναφορές
[1]. Αβραμιώτη Σ., Αγγελοπούλου Β., Καπελώνη Γ., Σινιγάλια Π., Σπαντίδη Δ.,
Τρικαλίτη Α., Φίλιου Γ. ΧΗΜΕΙΑ Β’ ΓΥΜΝΑΣΙΟΥ. Έκδοση ΙΤΥΕ
«Διόφαντος».
[2]. Ν. Αντωνίου, Π. Δημητριάδης, Κ. Καμπούρης, Κ. Παπαμιχάλης, Λ.
Παπατσίμπα. ΦΥΣΙΚΗ Γ’ ΓΥΜΝΑΣΙΟΥ. Έκδοση ΙΤΥΕ «Διόφαντος» .
[3]. Θεοδωρόπουλου Π., Παπαθεοφάνους Π., Σιδέρη Φ. ΧΗΜΕΙΑ Γ’
ΓΥΜΝΑΣΙΟΥ. Έκδοση ΙΤΥΕ «Διόφαντος» .
[4]. Σ. Λιοδάκη, Δ. Γάκη, Δ. Θεοδωρόπουλου, Π. Θεοδωρόπουλου, Αν. Κάλλη.
ΧΗΜΕΙΑ Α’ ΛΥΚΕΙΟΥ. Έκδοση ΙΤΥΕ «Διόφαντος».
[5]. Taber, K. S., & Coll, R. K. Chemical bonding. Chemical Educa
t
ion: Research-
based Prac
t
ice 2002 (pp. 213-234),
[6]. Lee, R. &. Cheng, Maurice M. W. The Rela
t
ionship Between Teaching and
LearningofChemicalBondingandStructures. Topics andTrends in Current
Science Educa
t
ion: 9th ESERA Conference Selected Contribu
t
ions 2014,
Πρόσθετο υλικό
Φύλλο εργασίας:
Ερωτηματολόγιο:
Βιογραφικά συγγραφέων
στη Δευτεροβάθμια Εκπαίδευση και από το 2013 στο
Εργαστηριακό Κέντρο Φυσικών Επιστημών Τούμπας. Στα
ενδιαφέροντα της κυριαρχεί η διδασκαλία των Φυσικών
Επιστημών με πειραματικές δραστηριότητες χρησιμοποιώντας
απλά υλικά και καθημερινές δραστηριότητες.
Σ
ω
στό
ή
λά
θ
ος
.
2
.Τ
ο
απ
ι
ον
ι
σμένο
νερό
ε
ί
να
ι κ
αλός
αγ
ω
γός
του
ηλε
κ
τρ
ι
σμού
.
Σ
ω
στό
ή
λά
θ
ος
.
3.Τ
α
ο
ξ
έα
ε
ί
να
ι
ομο
ι
οπολ
ικ
ές
εν
ώ
σε
ι
ς
.
Σ
το
δ
ι
άλυμα
ενός
ο
ξ
έος
αυτό
β
ρ
ί
σ
κ
ετα
ι
σε
μορ
φ
ή
ι
όντ
ω
ν
,
μορ
ίω
ν
ή
ι
όντ
ω
ν
κ
α
ι
μορ
ίω
ν
;
Υ
πογραμμ
ί
στε
τη
σ
ω
στή
απάντηση
.
Η Αναστασία Γκιγκούδη σπούδασε Χημεία
στοΑριστοτέλειοΠανεπιστήμιοΘεσσα-
λονίκης,είναι κάτοχοςμεταπτυχιακού
διπλώματος στη Διδακτική της Χημείας και τις
1.Τ
ο
ορυ
κ
τό
αλάτ
ι
ε
ί
να
ι
αγ
ω
γός
του
ηλε
κ
τρ
ι
σμού
.
Νέες Εκπαιδευτικές Τεχνολογίες, εργάζεται
Η Αγαθονίκη Μαμζερίδου σπούδασε Φυσική
στοΑριστοτέλειοΠανεπιστήμιοΘεσσα-
λονίκης.Είναι κάτοχοςμεταπτυχιακού
διπλώματος στη Ραδιοηλεκτρολογία.
Εργάζεται στη Δευτεροβάθμια Εκπαίδευση
από το 2001. Την σχολική χρονιά 2022-2023 υπήρξε
συνεργάτης του Ε.Κ.Φ.Ε. Κέντρου.
22
Τεύχος 1, Ιούλιος 2024
Προ
σ
ομο
ιώ
νοντ
α
ς
τη
λε
ι
τουργ
ί
α
του
κ
υ
κ
λο
φ
ορ
ικ
ού
σ
υ
σ
τήμ
α
τος
κ
α
ι
τη
σ
ύ
σ
τ
ασ
η
του
α
ί
μ
α
τος
Ελευθερία Παπαδέλη
2
ο
ΓΕΛ Κοζάνης & Ε.Κ.Φ.Ε. Κοζάνης
Λέ
ξ
ε
ι
ς
Κ
λε
ι
δ
ι
ά
: κ
υ
κ
λο
φ
ορ
ικ
ό
σύστημα
, κι
νητή
μά
θ
ηση
,
συνεργατ
ικ
ή
μά
θ
ηση
Περ
ί
λη
ψ
η
Η
δ
ι
δα
κ
τ
ικ
ή
παρέμ
β
αση
που
περ
ι
γρά
φ
ετα
ι
α
ξ
ι
οπο
ι
ε
ί
τ
ι
ς
αρ
χ
ές
της
βιω
ματ
ικ
ής
,
της
συνεργατ
ικ
ής
κ
α
ι
της
“κι
νητής
”
μά
θ
ησης
“ (“m
ob
i
le
learn
i
n
g”). Σχ
εδ
ι
άστη
κ
ε
κ
α
ι
υλοπο
ι
ή
θ
η
κ
ε
στο
Ε.Κ.Φ.Ε. (Ε
ργαστηρ
ι
α
κ
ό
Κ
έντρο
Φ
υσ
ικώ
ν
Ε
π
ι
στημ
ώ
ν
) Κ
ο
ζ
άνης
στο
πλα
ί
σ
ι
ο
μα
θ
ητ
ικώ
ν
επ
ι
σ
κ
έ
ψ
ε
ω
ν
κ
α
ι
στο
2ο
Γ
.Ε.
Λ
. Κ
ο
ζ
άνης
στο
πλα
ί
σ
ι
ο
του
μα
θ
ήματος
της
βι
ολογ
ί
ας
τον
Απρ
ί
λ
ι
ο
-Μ
ά
ι
ο
του
σ
χ
ολ
ικ
ού
έτους
2
0
2
1-
2
0
22
,
Απρ
ί
λ
ι
ο
-Μ
ά
ι
ο
του
σ
χ
ολ
ικ
ού
έτους
2
0
22
-
2
0
2
3 κ
α
ι
Απρ
ί
λ
ι
ο
-Μ
ά
ι
ο
του
σ
χ
ολ
ικ
ού
έτους
2
0
2
3-
2
0
24
. Μ
έσ
ω
τηςπαρέμ
β
ασηςο
ι
μα
θ
ητές
/
μα
θ
ήτρ
ι
εςπουσυμμετε
ίχ
αν
κ
λή
θ
η
κ
αννα
πραγματοπο
ι
ήσουν
εργαστηρ
ι
α
κ
ές
ασ
κ
ήσε
ι
ς
κ
α
ι
hand
s-
on
δραστηρ
ι
ότητες
σ
χ
ετ
ικ
ές
με
το
κ
υ
κ
λο
φ
ορ
ικ
ό
σύστημα
.
Γ
εν
ικ
ά
,
από
την
παρατήρηση
της
εργασ
ί
ας
τ
ω
ν
μα
θ
ητ
ώ
ν
/
μα
θ
ητρ
ιώ
ν
κ
ατά
τη
δ
ι
άρ
κ
ε
ι
α
της
παρέμ
β
ασης
,
από
τ
ι
ς
επ
ι
δόσε
ι
ς
τους
στ
ι
ς
δ
ι
αδραστ
ικ
ές
ασ
κ
ήσε
ι
ς
αλλά
κ
α
ι
από
τα
ερ
ω
τηματολόγ
ι
α
που
συμπλήρ
ω
σαν
προ
κ
ύπτε
ι
το
συμπέρασμα
ότ
ι
επ
ι
τεύ
χθ
η
κ
αν
ο
ι
στό
χ
ο
ι
που
τέ
θ
η
κ
αν
ε
ξ
αρ
χ
ής
.
Βιολογία
Εισαγωγή
Τοάρθροπεριγράφειμιαδιδακτικήπρόταση
διάρκειας δύο διδακτικών ωρών που σχεδιάστηκε και
εφαρμόστηκε τα τελευταία 3 σχολικά έτη στο Ε.Κ.Φ.Ε.
Κοζάνης στο πλαίσιο επισκέψεων μαθητών/μαθητριών
της Α’ Γυμνασίου και στο 2ο Γ.Ε.Λ. Κοζάνης στο πλαίσιο
της διδασκαλίας της ενότητας για το κυκλοφορικό
σύστημα της βιολογίας της Α’ Λυκείου.
Κατά την υλοποίηση της διδακτικής παρέμβασης
αξιοποιήθηκαν οι αρχές της βιωματικής μάθησης, της
“κινητής μάθησης” (mobile learning) και της εργασίας σε
ομάδες. Η χρήση κινητών συσκευών για εκπαιδευτικούς
σκοπούς προέκυψε ως αποτέλεσμα της διαδεδομένης
χρήσης της τεχνολογίας και της ανάγκης για εύκολη
πρόσβαση στην πληροφορία, οπουδήποτε και ανά πάσα
στιγμή [1]. Κατά τη συνεργατική μάθηση οι μαθητές
εργάζονται σε ομάδες για την επίτευξη ενός κοινού
σκοπού και ολοκληρώνουν το έργο τους χωρίς την άμεση
επίβλεψη και παρέμβαση του εκπαιδευτικού [2].
Για την υλοποίηση της παρέμβασης οι μαθητές/
μαθήτριες χωρίζονται σε πέντε ομάδες των 3-5 μαθητών.
Κάθε ομάδαδουλεύει σεένανπάγκο-σταθμό,στονοποίο
υπάρχει μια ξεχωριστή δραστηριότητα, και περνά
κυκλικά από όλους τους πάγκους. Με τον τρόπο αυτό
λύνεταικαιτοπρόβλημα που προκύπτει απότηνέλλειψη
εξοπλισμού για όλες τις ομάδες στα Σχολικά Εργαστήρια
Φυσικών Επιστημών (Σ.Ε.Φ.Ε.) και ενίοτε στα Ε.Κ.Φ.Ε.. Σε
κάθε πάγκο υπάρχουν ταμπλέτες και φωτοτυπημένοι
κωδικοί(QRcodes).Οιμαθητές/μαθήτριες,
αξιοποιώντας εφαρμογή (εργαλείοσάρωσης),
εγκατεστημένη στηνταμπλέτα της ομάδαςτους,
σαρώνουν τους κωδικούς καιοδηγούνται σε
βιντεοσκοπημένες οδηγίες για τα βήματα που πρέπει να
ακολουθήσουν σε κάθε πάγκο-σταθμό και σε
διαδραστικές ασκήσεις.
Μετά την ολοκλήρωση του σεναρίου αναμένεται οι
μαθητές και οι μαθήτριες να εξοικειωθούν με τη
σύσταση του αίματος, να περιγράφουν τη δομή και τη
Εικόνα 1. Προσομοιώνοντας τη σύσταση του αίματος.
Εικόνα 2. Παρατήρηση στο μικροσκόπιο και συνοδευτικές ασκήσεις.
24
Τεύχος 1
,
Ιούλιος 2024
λειτουργία της καρδιάς, να διακρίνουν τις αρτηρίες από
τις φλέβες, να εξασκηθούν στην παρατήρηση με το
οπτικό μικροσκόπιο και την εφαρμογή οδηγιών, να
αποκτήσουν δεξιότητες συνεργασίας και επικοινωνίας
και να αποκτήσουν θετική στάση απέναντι στη βιολογία
και τις φυσικές επιστήμες γενικότερα.
Περιγραφή παρέμβασης
Δραστηριότητα 1: Προσομοίωση των συστατικών του
αίματος
Στον πρώτο πάγκο-σταθμό οι μαθητές/μαθήτριες
ακολουθούν τις οδηγίες ενός διαδραστικού video, ώστε
να προσομοιώσουν με απλά υλικά (π.χ. χρώματα
ζαχαροπλαστικής,cheerios,marshmallows)τα
συστατικάτου αίματος. Μέσααπόαυτήτη
δραστηριότητα μαθαίνουν-θυμούνται ότι το υγρό του
αίματος (πλάσμα) είναι κίτρινο, ότι τα έμμορφα
συστατικά του αίματος είναι τα ερυθρά αιμοσφαίρια, τα
λευκά αιμοσφαίρια και τα αιμοπετάλια, ότι το αίμα
παίρνει το χρώμα του από τα ερυθρά αιμοσφαίρια και
ότι τα ερυθρά αιμοσφαίρια είναι τα πολυπληθέστερα
κύτταρα του αίματος, Εικόνα 1.
Δραστηριότητα 2: Παρατήρηση στο
μικροσκόπιο
Στον δεύτερο πάγκο-σταθμό οι
μαθητές/μαθήτριες παρατηρούν δύο
μόνιμα παρασκευάσματα στο
μικροσκόπιο:έναπαρασκεύασμα
κυττάρωντουαίματοςκιένα
παρασκεύασμα τομής αρτηρίας και
φλέβας, όπου φαίνεται καθαρά ότι
οι αρτηρίες διαθέτουν παχύτερα
τοιχώματα και μικρότερη διάμετρο,
ενώ οι φλέβες λεπτότερα τοιχώματα
και μεγαλύτερη διάμετρο. Μετά την
ολοκλήρωση της παρατήρησης
σαρώνουν QR codes, για να
οδηγηθούν σε σύντομες
διαδραστικές ασκήσεις σχετικές με
αυτά που παρατήρησαν, Εικόνα 2.
Δραστηριότητα3: Προσομοίωση της
δομής του κυκλοφορικού
συστήματος
Δραστηριότητα 4: Προσομοίωση της λειτουργίας της
καρδιάς
Στον τέταρτο πάγκο-σταθμό οι μαθητές/μαθήτριες
προσομοιώνουντηλειτουργίατηςκαρδιάς,
ακολουθώντας τις οδηγίες ενόςvideo, που στηρίχτηκε σε
δημοσιευμένο video της Π.Ε.Β. στο κανάλι της στο
YouTube [3]. Μέσα από αυτή τη δραστηριότητα
μαθαίνουν/θυμούνται ότι η καρδιά λειτουργεί ως μία
αντλία, που στέλνει το αίμα από τους κόλπους προς τις
κοιλίες και όχι αντίστροφα, Εικόνα 4.
Στοντρίτοπάγκο-σταθμόοι
μαθητές/μαθήτριεςπαρατηρούν-
προσομοιώνουντηδομήτου κυκλοφορικού
συστήματος, ακολουθώντας τις οδηγίες ενός video, και
υλοποιούνσύντομες διαδραστικές ασκήσεις.Στη
δραστηριότητα αξιοποιείται η καρδιάαπό το
πρόπλασμα του ανθρώπινου σώματος, που υπάρχει στα
περισσότερα Σ.Ε.Φ.Ε., καθώς και μπλε και κόκκινες
κορδέλες για προσομοίωση των φλεβών και των
αρτηριώναντίστοιχα, Εικόνα 3.Στόχοςτης
συγκεκριμένης δραστηριότητας είναι οι μαθητές να
μάθουν-θυμηθούν τη δομή της τετράχωρης καρδιάς του
ανθρώπου καθώς και τη ροή του αίματος κατά τη μικρή
και τη μεγάλη κυκλοφορία.
Πίνακας 1. Απαντήσεις σε ποσοστά επί τοις εκατό (%) στις ερωτήσεις
κλειστούτύπου(ΔΑ=διαφωνώαπόλυτα,ΣΛ=συμφωνώλίγο,
ΣΑ=συμφωνώ αρκετά ΣΠ= συμφωνώ πολύ ΣΑ= συμφωνώ απόλυτα).
ΔΑ
Συμμετείχα στο μάθημα.
ΣΛ ΣΑ ΣΠ ΣΑ
6 25 25 44
Κατανόησα τις έννοιες του μαθήματος
19193131
Το σημερινό μάθημα ανταποκρίθηκε
στις προσδοκίες μου.
13253131
Συνεργαστήκαμε καλά στην ομάδα
μου.
253144
Η ομάδα μου ολοκλήρωσε τις
δραστηριότητες.
6252544
Θα ήθελα το μάθημα της βιολογίας στο
σχολείο να συνοδεύεται από τέτοιες
δραστηριότητες.
6191956
25
Τεύχος 1
,
Ιούλιος 2024
Δραστηριότητα 5: Προσομοίωση της ροής του αίματος
Στον πέμπτο πάγκο-σταθμό οι μαθητές/μαθήτριες
προσομοιώνουν τη μικρή και τη μεγάλη κυκλοφορία με
απλά υλικά (τέσσερις σύριγγες, νερό, μπλε και κόκκινο
χρώμα ζαχαροπλαστικής, διαφανής σωλήνας σιλικόνης,
φωτοτυπίακαρδιάς,κόλλα),ακολουθώντας
βιντεοσκοπημένες οδηγίες, Εικόνα 4.
Αποτελέσματα
Συμπέρασμα
Η παρέμβαση συνολικά υλοποιήθηκε με 13 τμήματα
μαθητών/μαθητριών Α’ Γυμνασίου και Α’ Λυκείου, ήτοι
262 μαθητές & μαθήτριες. Στο τέλος της παρέμβασης οι
Εικόνα 4. Η καρδιά ως αντλία.
μαθητές/μαθήτριες αξιολόγησαν την παρέμβαση μέσω
φόρμας google. Στον Πίνακα 1 παρουσιάζονται τα
αποτελέσματα στις ερωτήσεις κλειστού τύπου, όπου
χρησιμοποιήθηκε 5-βαθμη κλίμακα Likert.
Στην ανοιχτή ερώτηση «Τι σου άρεσε περισσότερο»
27% απάντησαν ότι τους άρεσαν όλα. Στο 40% άρεσε
περισσότερο η δραστηριότητα με το μικροσκόπιο
(Δραστηριότητα 2), στο 6% η δραστηριότητα 5, στο 20%
η δραστηριότητα 1 και στο 7% η δραστηριότητα 3.
Αντιστοίχως, στην ανοιχτή ερώτηση «Τι θα άλλαζες/Τι
δεν σου άρεσε;» 56% απάντησαν ότι δεν θα άλλαζαν
κάτι, ενώ ένας/μία μαθητής/μαθήτρια απάντησε ότι δεν
του/της άρεσε που λερώθηκε με τα χρώματα.
Γενικά, από την παρατήρηση της εργασίας των
μαθητών/μαθητριών κατά τη διάρκεια της παρέμβασης,
Εικόνα 5. Η ροή του αίματος.
από τις επιδόσεις τους στις διαδραστικές ασκήσεις αλλά
Εικόνα 3. Προσομοίωση της δομής του κυκλοφορικού συστήματος και διαδραστική άσκηση.
26
Τεύχος 1
,
Ιούλιος 2024
καιαπόταερωτηματολόγιαπουσυμπλήρωσαν
προκύπτει το συμπέρασμα ότι οι στόχοι επιτεύχθηκαν. Η
επιτυχής διεξαγωγήτηςδιδακτικής παρέμβασης
οφείλεται ενδεχομένως στη συνεργατικήκαι ταυτόχρονα
βιωματική προσέγγιση που ακολουθήθηκε αλλά και στη
χρήση της τεχνολογίας και της “κινητής μάθησης”.
[1] Τalan, T. (2020). The Effect of Mobile Learning on Learning Performance: A
Meta-Analysis Study, Educational Sciences: Theory & Practice, 20, (1), 79-
103,
[2] Cohen, E. (1994). Restructuring the classroom: conditions for productive
small groups. Review of Educational Research, 64 (1), 1-35,
[3] Π.Ε.Β.,Γίνεβιολόγοςγιαμίαημέρα-Ημεγάληαντλία
Πρόσθετο υλικό
•
Video προς αξιοποίηση στη δραστηριότητα 1
•
Διαδραστικές ασκήσεις προς αξιοποίηση στη
δραστηριότητα 2
•
Video προς αξιοποίηση στη δραστηριότητα 3
•
Διαδραστικές ασκήσεις προς αξιοποίηση στη
δραστηριότητα 3
Βιβλιογραφικές Αναφορές
•
Video προς αξιοποίηση στη δραστηριότητα 4
•
Video προς αξιοποίηση στη δραστηριότητα 5
Βιογραφικό συγγραφέως
H Δρ. Παπαδέλη Ελευθερία είναι βιολόγος,
μόνιμηεκπαιδευτικόςαπότο2008.
Διετέλεσε υπεύθυνη του Ε.Κ.Φ.Ε. Κοζάνης
(Μάρτιος 2019 έως Σεπτέμβριος 2022).
‘Έκτοτε υπηρετεί στο 2ο ΓΕΛ Κοζάνης και
ταυτόχρονα είναι αποσπασμένη στο Ε.Κ.Φ.Ε.
Κοζάνης για δύο ημέρες την εβδομάδα. Είναι διδάκτωρ
παιδαγωγικήςτουΠ.Τ.Δ.Ε.τουΠανεπιστημίουΔυτ.
Μακεδονίας. Κατέχει δύο μεταπτυχιακούς τίτλους σπουδών
(στη Μοριακή Βιολογία και στην Προγεννητική Γενετική και
Εμβρυϊκή Ιατρική). Είναι ενεργό μέλος της ΠΑΝ.Ε.Κ.Φ.Ε. και
μέλος του Διοικητικού Συμβουλίου της Π.Ε.Β.
27
Τεύχος 1
,
Ιούλιος 2024
1
Σ
χολ
ι
κή
Σ
απ
ω
νο
π
ο
ί
ηση
:
γ
ι
α
μ
ικ
ρούς
(
ό
χι
γ
ι
α
πολύ
α
κ
όμα
) ε
π
ι
S
TE
A
M
ονες
Περ
ί
λη
ψ
η
Η
ανα
ζ
ήτηση
τρόπ
ω
ν
β
ελτ
ίω
σης
της
αποτελεσματ
ικ
ότητας
της
δ
ι
δασ
κ
αλ
ί
ας
κ
α
ι
προ
-
σαύ
ξ
ησης
του
ενδ
ι
α
φ
έροντος
τ
ω
ν
μα
θ
ητ
ώ
ν
συμ
β
αδ
ίζ
ε
ι
με
το
ευσυνε
ί
δητο
έργο
του
ε
κ
πα
ι
δευτ
ικ
ού
.
Η
εργαστηρ
ι
α
κ
ή
δραστηρ
ι
ότητα
της
σαπ
ω
νοπο
ί
ησης
αποτελε
ί
ενδ
ι
α
-
φ
έρουσα
,
ελ
κ
υστ
ικ
ή
,
δ
ι
επ
ι
στημον
ικ
ή
κ
α
ι βιω
ματ
ικ
ή
δραστηρ
ι
ότητα
περ
ιβ
αλλοντ
ικ
ής
αγ
ω
γής
γ
ι
α
την
ο
ικ
ονομ
ί
α
κ
α
ι
την
αε
ι
φ
ορ
ί
α
.
Δ
ι
α
χ
ρον
ικ
ά
υλοπο
ι
ε
ί
τα
ι
σε
κ
ατάλληλα
ε
-
ξ
οπλ
ι
σμένους
χώ
ρους
εργοστασ
ίω
ν
σαπ
ω
νοπο
ιί
ας
κ
α
ι
σε
πρόσ
κ
α
ι
ρα
ο
ικι
α
κ
ά
εργα
-
στήρ
ι
α
. Σ
υνυ
φ
ασμένη
με
τε
χ
νο
-
επ
ι
στημον
ικ
ές
,
δημ
ι
ουργ
ικ
ές
,
ο
ικ
ονομ
ικ
ές
αλλά
κ
α
ι
λαογρα
φ
ικ
ές
κ
α
ι κ
αλλ
ι
τε
χ
ν
ικ
ές
παραμέτρους
,
γ
ί
νετα
ι
η
α
φ
ορμή
γ
ι
α
την
ε
φ
αρμογή
του
δ
ι
δα
κ
τ
ικ
ού
μοντέλου
«
S
TE
A
M»
στο
πλα
ί
σ
ι
ο
τ
ω
ν
Ε
ργαστηρ
ίω
ν
Δε
ξ
ι
οτήτ
ω
ν
της
Σ
τ
΄
Δη
-
μοτ
ικ
ού
.
Πλα
ί
σ
ι
ο
ε
φ
αρμογής
του
εγ
χ
ε
ι
ρήματος
αποτελε
ί
η
ανα
κ
αλυπτ
ικ
ή
,
δ
ι
ευρευνη
-
τ
ικ
ή
κ
α
ι
συνεργατ
ικ
ή
μά
θ
ηση
μέσα
από
το
πε
ί
ραμα
.
Χ
ώ
ρος
π
ι
λοτ
ικ
ής
δ
ι
ε
ξ
αγ
ω
γής
της
δ
ι
αδ
ικ
ασ
ί
ας
που
περ
ι
γρά
φ
ετα
ι
στο
άρ
θ
ρο
αυτό
ε
ί
να
ι
η
σ
χ
ολ
ικ
ή
α
ίθ
ουσα
της
Σ
τ
΄
τά
ξ
ης
του
Δημοτ
ικ
ού
Σχ
ολε
ί
ου
Παπαδ
ι
αν
ίκω
ν
Λα
κω
ν
ί
ας
.
Λέ
ξ
ε
ι
ς
Κ
λε
ι
δ
ι
ά
:
σαπ
ω
νοπο
ί
ηση
,
αε
ι
φ
ορ
ί
α
,
εργαστήρ
ι
α
δε
ξ
ι
οτήτ
ω
ν
,
S
TE
A
M
Δημοτικό - Νηπιαγωγείο
Σταυρούλα Γατή
Εκπαιδευτικός κλ.ΠΕ70,
Δημοτικό Σχολείο Παπαδιανίκων Λακωνίας
Ελένη Παλούμπα
Εκπαιδευτικός κλ.ΠΕ04.02,
Υπεύθυνη του Ε.Κ.Φ.Ε. Λακωνίας
Τεύχος 1, Ιούλιος 2024
βουλία [1], με την επιμέρους θεματική υποενότητα
«STEAM», διασταυρώνεται διεπιστημονικά με τα μαθή-
ματα της Γλώσσας, των Μαθηματικών, της Φυσικής και
των Εικαστικών του Αναλυτικού Προγράμματος Σπου-
δών. Η συνεργασία του Δημοτικού Σχολείου Παπαδιανί-
κων με το Εργαστηριακό Κέντρο Φυσικών Επιστημών
(Ε.Κ.Φ.Ε.) Λακωνίας, έφερε ως αποτέλεσμα στους μαθη-
τές την παρακάτω διδακτική προσέγγιση, η οποία κατα-
τίθεται ως δοκιμασμένη αξιόλογη διδακτική πρακτική,
τόσο για το περιεχόμενο όσο και για την πολυθεματική
της ευελιξία.
Αφόρμηση
Ως αφόρμηση για το θέμα, χρησιμοποιείται το βίντεο
με τίτλο
[2], Εικόνα 1. Το βίντεο αναφέρεται στον τρόπο
με τον οποίο συλλέγονται, επεξεργάζονται και ανακυ-
κλώνονται τα τηγανέλαια καθώς και στο είδος των προϊ-
όντων που μπορούν να προσφέρουν. Ακολουθεί συζή-
τηση κατά την οποία οι μαθητές αναφέρουν τις σχετικές
εμπειρίες τους από το οικογενειακό τους περιβάλλον κι
έπειτα δημιουργούν εννοιολογικό χάρτη με το ψηφιακό
εργαλείο (CmapsTools) (Τechnology), Εικόνα 2. Σε αυτόν
καταγράφονται οι βασικές έννοιες, οι λέξεις κλειδιά και
οι σκέψεις που προκύπτουν από τον καταιγισμό ιδεών
και τη συζήτηση που έχει προηγηθεί. Με αυτόν τον
τρόποοι μαθητές εισάγονταιστοθέμα, ευαισθητοποιού-
νται για την αναγκαιότητα ανακύκλωσης των χρησιμο-
ποιημένων ελαίων, καλούνται να επιλύσουν ένα
Εισαγωγή
Ι δεξιότητες του 21ου αιώνα, των οποίων η συ-
χνότητα εφαρμογής βαίνει αξιοσημείωτα αυξα-
νόμενη στην ελληνική εκπαιδευτική πραγματικότητα, υ-
ποστηρίζονται εμφανώς στο συγκεκριμένο σχέδιο δρά-
σης. Δεξιότητες μάθησης, επιχειρηματικότητας, κοινωνι-
κής ζωής, συνεργασίας, τεχνολογίας, στρατηγικής σκέ-
ψης, δημιουργικότητας και παραγωγικότητας, καλλιερ-
γούνται κι ενδυναμώνονται. Η ελιά, το ελαιόλαδο και τα
παράγωγά του, πάντα εμπίπτουν στο ενδιαφέρον των
σχολικών δραστηριοτήτων της ευρύτερης περιοχής της
Λακωνίας, αλλά και πολλών άλλων αγροτικών περιοχών
της Ελλάδας, δεδομένου ότι τα προϊόντα αυτά αποτε-
λούν αναπόσπαστο κομμάτι της τοπικής ανάπτυξης και
της καθημερινότητας των κατοίκων. Ο Θεματικός Κύκλος
των Εργαστηρίων Δεξιοτήτων της Στ΄ τάξης με τίτλο: Δη-
μιουργώ και Καινοτομώ - Δημιουργική Σκέψη και Πρωτο-
Ο
Εικόνα 1.Εισαγωγή στη Σαπωνοποίηση.
Εικόνα 2. Εννοιολογικός χάρτης που δημιούργησαν οι
μαθητές.
29
προϊόν, συνδυάζοντας διεπιστημονικά διάφορους κλά-
δους.
Κατάρτιση Σχεδίου Δράσης - Engineering
Σε επόμενο εργαστήριο, προβάλλεται ένα δεύτερο βί-
ντεο με τίτλο
[3], από το οποίο προκύπτει η ανάγκη χρήσης ε-
νός πρωτοκόλλου βημάτων. Ακολουθεί χωρισμός σε ο-
μάδες 3-4 ατόμων, μεικτών ως προς το φύλο και τις ικα-
νότητες. Η κάθε ομάδα ορίζει διακριτούς ρόλους στα
μέλη της. Οι ομάδες διατηρούνται ως το τέλος της δρά-
σης. Μετην καθοδήγησητης εκπαιδευτικού κάθε ομάδα
απαντά σεερωτήσεις σχετικέςμε τα απαιτούμεναυλικά,
τα μέσα και ταεργαλεία, τις ποσότητες και τηνπηγήπρο-
μήθειας των υλικών, τους ενδεχόμενους κινδύνους και
τους τρόπους αντιμετώπισης, τα ενδεδειγμένα μέτρα α-
σφάλειας, τη διαρρύθμιση της τάξης κλπ. Όλος ο σχεδια-
σμός καταγράφεται από τον υπεύθυνο μαθητή κάθε ο-
μάδας.
Ενθαρρύνονταιέτσι ηπεριέργεια,η έρευνακαιη πρό-
κληση σχεδιασμού, θεμελιώνεται η μάθηση βάσει προ-
βλημάτωνκαιοικοδομούνταιβασικέςδεξιότητες
(Engineering).
Παρασκευή Σαπουνιού–STEM
Η διδακτική παρέμβαση για την εργαστηριακή δρα-
στηριότητα της σαπωνοποίησης οργανώνεται χρονικάσε
δύο μέρη και σε δύο διδακτικές ώρες αντίστοιχα:
Στο 1ο μέρος προβάλλεται ολιγόλεπτη σειρά διαφα-
νειών μέσω της οποίας οι μαθητές ενημερώνονται για το
θέμα, τον σκοπό και τους στόχους. Αξιοποιείται το υλικό
της ηλεκτρονικής πλατφόρμας
, για την ι-
διαιτερότητα της δομής του μορίου του σαπουνιού και
την απορρυπαντική του λειτουργία. Αξιοποιούνται πλα-
στικά προσομοιώματα μορίων του σαπουνιού (δεκαεξα-
νικού ή παλμιτικού νατρίου) και της γλυκερίνης. Ανιχνεύ-
ονται εναλλακτικές ιδέες των παιδιών, ενθαρρύνεται η
συζήτηση, κατατίθενται νέες ιδέεςκαι εξάγεται -προσαρ-
μοσμένο στη βαθμίδα του δημοτικού- το βασικό επιστη-
μονικό υπόβαθρο.
Παρουσιάζεται το παιγνιώδες σενάριο της δραστη-
ριότητας, σύμφωνα με το οποίο ένα ζεύγος κερδοσκό-
πων σαπωνοποιών
προσλαμβάνει ως υπαλλήλους του σαπωνοποιείου τους
μαθητές της συγκεκριμένης τάξης, πλην όμως, το ζεύγος
πρόβλημα και στη συνέχεια να δημιουργήσουν έναλαμβάνει μέτρα για τη διατήρηση της μυστικότητας της
πολύτιμης συνταγής. Γι’ αυτό αυτή δίνεται αποσπασμα-
τικά, γραμμένη με γρίφους και, ποτέ σε έναν μόνο, αλλά
σε δύο «υπαλλήλους», ώστε «να έχουν τα χέρια τέσ-
σερα, τα μάτια δεκατέσσερα». Τα παιδιά, σε ζεύγη, φο-
ρούν εργαστηριακές μπλούζες, γυαλιά και γάντια και πα-
ραλαμβάνουν διαδοχικά τους
Έτσι ακολουθούντα «σωστά βήματα» της διαδικα-
σίας σαπωνοποίησης, τα οποία στο τέλος καλούνται να
διατυπώσουν ως ομάδα και ως ολομέλεια της τάξης τους
για χάρη της συνεργασίας, της προόδου και της επιστή-
μης.
Στο 2ο μέρος της διδακτικής παρέμβασης, τα παιδιά
αποκωδικοποιούν σταδιακά τις οδηγίες και τις υλοποι-
ούν. Ζυγίζουν τα υλικά, θερμομετρούν, αναδεύουν, σχο-
λιάζουν και συζητούν εποικοδομητικά. Συνεισφέρουν ό-
λοι στη δημιουργία του τελικού προϊόντος, έτσι ώστε να
το θεωρούν «δικό τους».
Η διάλυση του ΝαΟΗ γίνεται από τον/την εκπαιδευ-
τικό και όχι από τα παιδιά. Τονίζεται η επικινδυνότητα
και συζητώνται τα μέτρα ασφαλείας γενικότερα. Ο/η εκ-
παιδευτικός έχει ρόλο κατά βάση συμβουλευτικό. Δίνει
οδηγίες όπου απαιτείται. Επιβλέπει, υποστηρίζει, ενι-
σχύει κι επιβραβεύει την προσπάθεια των μαθητών.
Ως προς την υλικοτεχνική υποδομή, οι μαθητές εργά-
στηκαν σε πρόσκαιρο εργαστήριο στη σχολική τους αί-
θουσα, μπορούν όμως να εργαστούν στο Σχολικό Εργα-
στήριο Φυσικών Επιστημών, αλλά και στο πλαίσιο εκπαι-
δευτικής επίσκεψης σε θεματικό μουσείο (π.χ. Μουσείο
Ελιάς κι Ελληνικού Λαδιού στη Σπάρτη) ή στο οικείο
Ε.Κ.Φ.Ε.
Ένας βιντεοπροβολέας αναβαθμίζει τη διδακτική δια-
δικασία. Σκεύη, όργανα και υλικά μπορούν να βρεθούν
σχετικά εύκολα.
Κατά την υλοποίηση της εργαστηριακής άσκησης στη
σχολική αίθουσα, το γυάλινο ποτήρι ζέσεως έχει αντικα-
τασταθεί από μεταλλική κατσαρόλα και ο λύχνος Bunsen
από ηλεκτρική εστία, γιατον περιορισμό πιθανών ατυχη-
μάτων.
Στις
έχουν επιμεριστεί οι οδηγίες του
φύλλου εργασίας, έτσι ώστε να ενδιαφερθεί και να ασχο-
ληθεί ενεργά το σύνολο της τάξης. Βάσει των οδηγιών
αυτών, οι μαθητές τελικά παρασκευάζουν σε πραγματι-
κές συνθήκες το δικό τους σαπούνι, Εικόνα 3.
Η αξιολόγηση είναι διακριτική και συνεχής, ενώ στο
τέλος δίνεται σύντομο φύλλο αξιολόγησης, έντυπο ή η-
λεκτρονικό
, αν στο σχολείο υπάρχουν
30
Τεύχος 1, Ιούλιος 2024
Συσκευασία–διαφήμιση
Mathematics, Art, Technology, Engineering
Όταν το σαπούνι είναι έτοιμο προς χρήση, οι ομάδες
κάνοντας τους απαραίτητους υπολογισμούς διαίρεσης
της επιφάνειας σε ίσα ορθογώνια τμήματα (MATHS -
σύνδεσημε Μαθηματικά,τάξη Στ’,Θεματική ενότητα6η)
και χρησιμοποιώντας κατάλληλα εργαλεία, χαράσσουν
και κόβουν τα σαπούνια τους. Στη συνέχεια τα συσκευά-
ζουν σε επιλεγμένη χάρτινη συσκευασία, την οποία και
διακοσμούν επιμελώς, Εικόνα 4. Δίνουν όνομα και ει-
κόνα – ζωγραφιά ως λογότυπο, ενώ δημιουργούν και ευ-
φάνταστοσλόγκανγιατοπροϊόντους. Σε αυτότοσημείο
εμπλέκεται το μάθημα της Γλώσσας της Στ΄ τάξης και πιο
συγκεκριμένα η ενότητα «Διατροφή» και η δημιουργία
διαφήμισης. (Art)
Αξιολόγηση – διάχυση
Πραγματοποιείται προφορική αξιολόγηση και δια-
ξιοποιηθεί το ψηφιακό εργαλείο
.
Στο φύλλο αξιολόγησης αποτυπώνεται ο βαθμός επί-
τευξης των διδακτικών στόχων. Επιπλέον, οι μαθητές κα-
λούνται να καταθέσουν τις θετικές ή/και αρνητικέςεντυ-
πώσεις τους και τις προτάσεις τους για βελτίωση του μα-
θήματος που παρακολούθησαν. Τέλος, καλούνται να συ-
νεργαστούν στην κατεύθυνση της διάχυσης των αποτε-
λεσμάτων και να συνθέσουν τα βήματα της
, όπως τα αποκωδικοποίησαν και τα υλοποίη-
σαν.
διαθέσιμες ηλεκτρονικέςσυσκευές. Ανόχι,μεκατάλληλη Τουρκία και την Ιορδανία. Η δράση διαρκεί συνολικά 14
προετοιμασία από τον/την εκπαιδευτικό, μπορεί να α- ώρες και εντάσσεται σε δύο ενότητες των Εργαστηρίων
Δεξιοτήτων, συνδυάζοντας μαθήματα Γλώσσας, Μαθη-
ματικών, Φυσικών, Πληροφορικής και Αγγλικής γλώσ-
σας, στο πλαίσιο σχετικών δραστηριοτήτων του σχολι-
κού εγχειριδίου, όπως προτείνεται και από τον εξορθο-
λογισμό της διδακτέας ύλης [4].
Συμπεράσματα
Η διαθεματικότητα, η απλότητα, η ευελιξία και η συ-
νεργατική ανακάλυψη γνώσης είναι βασικά χαρακτηρι-
στικά αυτής της δραστηριότητας. Το ενδιαφέρον που εκ-
δήλωσαν οι μαθητές, ιδιαίτερα στις βιωματικές – hands
οn διδακτικές πρακτικές, αποδεικνύει την προστιθέμενη
αξία και την ωφελιμότητα της συνολικής διδακτικής προ-
σέγγισης. Η εργαστηριακή δραστηριότητα της σαπωνο-
ποίησης έχει υλοποιηθεί επανειλημμένα και εξακολου-
θεί να υλοποιείται συστηματικά στο πλαίσιο των δρά-
σεων τουΕ.Κ.Φ.Ε. σε σχολείατης Δευτεροβάθμιας Εκπαί-
δευσης. Η εφαρμογή σε μαθητές Δημοτικού έχει
διευρυμένο διδακτικό πρόγραμμα με τίτλο «Οι θησαυ-
ροί της Μεσογείου», το οποίο περιλαμβάνει θέματα ό-
πως το αμπέλι, το ψωμί, το λάδι, και τη Μεσογειακή δια-
τροφή. Περιλαμβάνει επίσης εκπαιδευτικές επισκέψεις
και συνεργασίες με διάφορους φορείς, όπως το ΚΕΠΕΑ
Μολάων και το Μουσείο Ελιάς κι Ελληνικού Λαδιού. Το
πρόγραμμα υλοποιείται και μέσω e-twinning σε συνερ-
γασία με σχολεία από την Ισπανία, την Ιταλία, την
Εικόνα 4.Δείγμα των επιμελημένων προϊόντων.
μορφωτική συζήτηση κατά τη διάρκεια των επιμέρους
δράσεων. Επίσης στο τέλος γίνεται γραπτή, ατομική α-
Εικόνα 3.Συνεργατική αποκωδικοποίηση των γρίφωv.
ξιολόγηση.
Οι μαθητές/τριες παρουσιάζουν τα έργα τους σε άλλες
τάξεις, προωθώντας την αξία της ανακύκλωσης, ενώ η
δράση δημοσιοποιείται στην ιστοσελίδα και στα κοινω-
νικά δίκτυα του σχολείου. Η δράση εντάσσεται σε ένα
31
Τεύχος 1, Ιούλιος 2024
τητα, τη συσχέτιση εφαρμογών της Χημείας με την καθη-
μερινή ζωή και με σύντομες αναφορές στον μικρόκοσμο,
προσαρμοσμένες στο γνωστικό επίπεδο των παιδιών. Η
δημιουργία κλίματος επικοινωνίας, συνεργασίας και συ-
ναπόφασης στην τάξη για τη διατύπωση υποθέσεων, τον
πειραματισμό και την εξαγωγή τεκμηριωμένων συμπε-
ρασμάτων, διαπιστώθηκε επανειλημμένα πως καλλιερ-
γεί τη θετική στάση των παιδιών για τις Φυσικές Επιστή-
μες και ισχυροποιεί την πιθανότητα να γίνουν περιβαλ-
λοντικά ευαισθητοποιημένοι και τεχνοεπιστημονικά εγ-
γράμματοι πολίτες. Τέλος, πολύτιμο στοιχείο σε όλη τη
διάρκεια εφαρμογής του προγράμματος, στάθηκε η συ-
νεργασία των εκπαιδευτικών όλων των ειδικοτήτων με
την εκπαιδευτικό της Στ΄ τάξης. Επιπλέον υποστηρικτικό
της δράσης υλικό, ιδέες και γνώσεις του οποίου αξιοποι-
ήθηκαν σε όλη τη διάρκεια της προαναφερθείσας δρά-
σης καθώς και στο παρόν άρθρο, έχει συγκεντρωθε
[1]. ΙΕΠ, Εργαστήρια Δεξιοτήτων 21+, Προγράμματα & Εφαρμογές Εργαστη-
ρίων από την Πιλοτική Εφαρμογή & Νέες προτάσεις Φορέων,
[2]. ΑΚΤΙ Project and Research Centre, Τηγανοκίνηση – Το ημερολόγιο μιας μα-
θήτριας, https://www.youtube.com/watch?v=NK6dqyBUQdk
[3]. SophiaKou, Φτιάξε αγνό σπιτικό σαπούνι – ψυχρή μέθοδος,
[4]. ESOS, Οδηγίες για τη διδασκαλία των μαθημάτων τουΔημοτικού σχολείου
για το σχολικό έτος 2023-2024
Πρόσθετο υλικό
1.
2.
3.
4.
5.
6.
7.
8.
Βιογραφικά συγγραφέων
ήταν η πρώτη φορά που εντάχθηκε στο ευρύτερο πλαί-
σιο των Εργαστηρίων Δεξιοτήτων της βαθμίδας αυτής.
Στα θετικά σημεία συγκαταλέγεται η παιγνιώδης διά-
σταση που προσελκύει το ενδιαφέρον και προσαυξάνει
τον ενθουσιασμό των παιδιών. Η -δικαιολογημένα- ελλι-
πής εξοικείωση των μαθητών/τριών με φαινόμενα, έν-
νοιες και όρους επιστημονικούς που αφορούν στον μι-
κρόκοσμο, αποτελεί δυσκολία, ο τρόπος προσέγγισης
της οποίας εναπόκειται στην κρίση του/της εκπαιδευτι-
κού. Στην περίπτωση μας η άμβλυνση επιχειρήθηκε με
την εστίαση στη δημιουργικότητα, τη διεπιστημονικό-
πραγματοποιηθεί πέντε φορές σε διαφορετικά Δημοτικά
σχολεία του νομού, με μαθητές/τριες Στ΄ Δημοτικού, ενώ
Βιβλιογραφικές-
Διαδικτυακές
Αναφορές
Η Ελένη Παλούμπα είναι υπεύθυνη του
Ε.Κ.Φ.Ε. Λακωνίας, Χημικός, με μεταπτυχιακές
σπουδές στην Εκπαίδευση και την Επικοινω-
νία της Επιστήμης. Συμμετέχει σε επιμορφω-
τικές δράσεις, συνέδρια κι εκπαιδευτικά προ-
γράμματα και συνεργάζεται με φορείς για την υποστήριξη της
εργαστηριακής διδασκαλίας των Φυσικών Επιστημών. Έχει λά-
βει διακρίσεις για καινοτόμες εκπαιδευτικές δραστηριότητες
και για πρωτότυπο εκπαιδευτικό υλικό. Τα ενδιαφέροντά της
επικεντρώνονται στη βελτίωση της εκπαίδευσης του σήμερα,
για την κατάκτηση ενός αρμονικά βιώσιμου κι ελπιδοφόρου
αύριο.
Η Σταυρούλα Γατή είναι απόφοιτη του Παιδα-
γωγικού Τμήματος του Πανεπιστημίου Αι-
γαίου και κάτοχος μεταπτυχιακού διπλώμα-
τος στην «Εκπαιδευτική Ηγεσία και Διοί-
κηση». Εργάζεται ως δασκάλα τα τελευταία
15 έτη και είναι υποστηρίκτρια της δια βίου μάθησης. Παρακο-
λουθεί συνεχώς ποικίλα επιμορφωτικά προγράμματα που θε-
ωρεί ότι αναβαθμίζουν τηνποιότητα της διδασκαλίας της. Συμ-
μετέχει με τους μαθητές της σε διαγωνισμούς, προγράμματα
STEM, συνεργασίες με σχολεία του εξωτερικού για τα οποία έ-
χει λάβει διακρίσεις.
32
Τεύχος 1, Ιούλιος 2024
Αν
ά
λυση
βί
ντεο
:
το
ελεύ
θ
ερο
λογ
ι
σμ
ικ
ό
T
ra
ck
er
Βασίλης Νούσης
Υπ. Ε.Κ.Φ.Ε. Θεσπρωτίας ΠΕ04.01
ahoo.gr
Περ
ί
λη
ψ
η
Λέ
ξ
ε
ι
ς
Κ
λε
ι
δ
ι
ά
:
ανάλυση
βί
ντεο
, T
ra
ck
er
, ιχ
νηλασ
ί
α
Η
ανάλυση
βί
ντεο
ε
ί
να
ι
μ
ι
α
μοντέρνα
πε
ι
ραματ
ικ
ή
μέ
θ
οδος
,
που
συν
ί
στατα
ι
στην
κ
αταγρα
φ
ή
ενός
φ
α
ι
νομένου
σε
αρ
χ
ε
ί
ο
ψ
η
φ
ι
α
κ
ού
βί
ντεο
κ
α
ι
την
επε
ξ
εργασ
ί
α
του
με
κ
ατάλληλο
λογ
ι
σμ
ικ
ό
, ώ
στε
να
ε
ξ
α
χθ
ούν
πληρο
φ
ορ
ί
ες
κ
α
ι
πε
ι
ραματ
ικ
ά
δεδομένα
,
τα
οπο
ί
α
α
φ
ορούν
το
φ
α
ι
νόμενο
όπ
ω
ς
πραγματοπο
ι
ε
ί
τα
ι
στον
πραγματ
ικ
ό
κ
όσμο
. Έχ
ε
ι
πολλά
κ
α
ι
σημαντ
ικ
ά
πλεονε
κ
τήματα
σε
σ
χ
έση
με
τ
ι
ς
παραδοσ
ι
α
κ
ές
εργαστηρ
ι
α
κ
ές
τε
χ
ν
ικ
ές
,
εν
ώ
μετα
ξ
ύ
τ
ω
ν
λογ
ι
σμ
ικώ
ν
ανάλυσης
βί
ντεο
,
ε
ξ
έ
χ
ουσα
θ
έση
κ
αταλαμ
β
άνε
ι
το
ανο
ικ
τού
κώ
δ
ικ
α
T
ra
ck
er
,
που
δημ
ι
ούργησε
ο
κ
α
θ
ηγητής
Dou
g
la
s B
rown
κ
α
ι
δ
ι
ατ
ίθ
ετα
ι
ελεύ
θ
ερα
.
Διαθεματικό
Στην περίπτωση της πειραματικής διδασκαλίας των
Φυσικών Επιστημών οι κύριοι τρόποι αξιοποίησης των
νέων τεχνολογιών ταξινομούνται σε δυο κατηγορίες:
•
Το εργαστήριο βασισμένο σε μικροεπεξεργαστές
(microprocessor-based laboratory ή MBL ), που
στηρίζεται σε μικροϋπολογιστικά συστήματα και
αισθητήρες, καθώς και τα αντίστοιχα λογισμικά για τη
λήψη, απεικόνιση και ανάλυση των πειραματικών
δεδομένων.
•
Το εργαστήριο βασισμένο σε βίντεο (video-based
laboratory ή VBL), που στηρίζεται σε λογισμικά
ανάλυσης βίντεο για τη μελέτη αντικειμένων σε
κίνηση (Εικόνα 1).
Η ανάλυση βίντεο
1. Αναδρομή
Ηανάλυσηβίντεοείναιμιατεχνικήπου
χρησιμοποιείται για τη λήψη πληροφοριών σχετικά με
κινούμενα αντικείμενα που καταγράφονται σε κάποιο
αρχείο βίντεο. Οι πρώτες προσπάθειες μελέτης μιας
κίνησης με τη χρήσητης τεχνολογίας ανάγονταιστα τέλη
του19
ου
αιώναμε την ανακάλυψη της
χρονοφωτογραφίας.
Εισαγωγή
ι ψηφιακές τεχνολογίες όπως οι υπολογιστές, οι
κινητές συσκευές, τα εργαλεία δημιουργίας και
διανομής ψηφιακών μέσων, τα εκπαιδευτικά
λογισμικά, οι ιστότοποι κοινωνικής δικτύωσης, κ.λ.π.
έχουνμεταμορφώσειτοντρόπομετονοποίο
σκεφτόμαστε το σχολείο και τη μάθηση [1] και οδηγούν
αναπόφευκτα στην αλλαγή του τρόπου με τον οποίο
διδάσκουμε. Η έρευνα[2],[3],[4] έχει αναδείξει πληθώρα
πλεονεκτημάτωναπό τη χρήση των ψηφιακών
τεχνολογιών στην εκπαίδευση των Φυσικών Επιστημών
αφού μεταξύ άλλων: κάνουντις επιστήμεςπιο
ενδιαφέρουσες, συμβάλλουν στην ανάπτυξη δεξιοτήτων
και κριτικής σκέψης, προσφέρουν ευκολία συλλογής και
χειρισμούδεδομένων και συνεπώς αφήνουν
περισσότερο χρόνο για παρατήρηση και συζήτηση,
αυξάνουν τις ευκαιρίες για επικοινωνία και συνεργασία
καθώς και την πρόσβαση στη γνώση μέσω της
οπτικοποίησης και των πολλαπλών αναπαραστάσεων.
Πρέπει βέβαια να τονιστεί πως η χρήση των νέων
τεχνολογιών δεν υποστηρίζει αυτόματα τη μάθηση [5],
αλλά οι δεξιότητες των ίδιων των εκπαιδευτικών στη
χρήση των νέων τεχνολογιών και οι στρατηγικές
διδασκαλίας που εφαρμόζουν αποτελούν καθοριστικούς
παράγοντες [6].
Ο
Εικόνα 1. Ανάλυση βίντεο με το Tracker
34
Τεύχος 1
,
Ιούλιος 2024
φυσικά φαινόμενα [8].
Με την ανάπτυξη στα μέσα της δεκαετίας του 1950
ιδιαίτερα του στίβου, για τη βελτίωση της τεχνικής και
της απόδοσης. Ωστόσο, η εμφάνιση της τεχνολογίας
ψηφιακούβίντεοκαιηαύξησητης υπολογιστικής ισχύος
στα τέλη του 20
ου
αιώνα, καθιέρωσαν την ανάλυση
βίντεο ως βασικό εργαλείο σε διάφορους τομείς, όπως ο
αθλητισμός, η ιατρική, η ασφάλεια, κ.ά.
Τις δεκαετίες 1950 και 1960 η Berenice Abbot στο
έργο “Documen
t
ing Science” χρησιμοποίησε τεχνικές
φωτογραφίας υψηλής ταχύτητας και στροβοσκοπίας,
Ο Άγγλος φωτογράφος Eadweard Muybridge [7]Την ίδια περίοδο εμφανίζονται και τα πρώτα
μεταξύ 1878 και 1886 χρησιμοποιώντας πολλαπλές λογισμικά για την αξιοποίηση της ανάλυσης βίντεο στη
κάμερεςκατέγραψε σειρές διαδοχικώνεικόνωνζώωνκαι διδασκαλία της Φυσικής [9], ενώ στις αρχές του 21
ου
ανθρώπων σε κίνηση, Εικόνα 2. αιώνα «η αξία της ανάλυσης βίντεο είναι καλά
εδραιωμένη» αναφέρει ο Douglas Brown [10], ο οποίος
δύο χρόνια νωρίτερα είχε παρουσιάσει το λογισμικό
ανάλυσης βίντεο Tracker. Τα χρόνια που ακολούθησαν
Εικόνα 3, για να απεικονίσει γρήγορα μεταβαλλόμεναεφαρμογές ανάλυσης βίντεο ενσωματώθηκαν στα
υπάρχοντα προγράμματα που συνόδευαν τα συστήματα
συγχρονικής λήψης και απεικόνισης μεγάλων εταιρειών
τηςπρώτηςπρακτικήςσυσκευήςεγγραφήςτου χώρου, όπως π.χ. στο Logger Pro της Vernier ή το
βιντεοταινίας, η ανάλυση βίντεο άρχισε να κερδίζειCapstone της Pasco.
έδαφος ως εργαλείο στον τομέα του αθλητισμού,
2. Βασική λειτουργία
Ανεξάρτητα από το χρησιμοποιούμενο λογισμικό η
αξιοποίησητηςανάλυσηςβίντεοστιςΦυσικές
Επιστήμες απαιτεί την ύπαρξη ενός αρχείου ψηφιακού
βίντεο, στο οποίο να έχει καταγραφεί το προς μελέτη
φαινόμενο(π.χ.ηκίνησηενόςσώματος)και
πραγματοποιείται ακολουθώντας τις ίδιες πρακτικά
βασικές αρχές:
•
Το λογισμικό μετατρέπει το αρχείο ψηφιακού βίντεο
σε μια σειρά διαδοχικών εικόνων, που κάθε μια
διαφέρει από την προηγούμενή της το ίδιο χρονικό
διάστημα, που καθορίζεται από την ταχύτητα των
καρέ (fps) του βίντεο.
•
Ρυθμίζεται το τμήμα του βίντεο που θα αναλυθεί
(βίντεο-κλιπ), αν το βίντεο έχει διάρκεια μεγαλύτερη
από αυτή του φαινομένου που μας ενδιαφέρει.
•
Βαθμονομείται το βίντεο-κλιπ, ώστε να είναι δυνατή
η μετατροπή μιας απόστασης μετρημένης σε pixels
επί της οθόνης του υπολογιστή στην αντίστοιχη
απόστασηστονπραγματικόκόσμο.Γιατη
βαθμονόμηση είναι απαραίτητο στο βίντεο να
καταγράφεται κάποιο αντικείμενο με γνωστές τις
διαστάσεις του στον πραγματικό κόσμο.
Εικόνα 3. Μια από τις πολύ γνωστές φωτογραφίες της
Berenice Abbot
Εικόνα 2. Σειρά διαδοχικών φωτογραφιών αλόγου σε καλπασμό του Eadweard Muybridge
35
Τεύχος 1
,
Ιούλιος 2024
Τα κύρια πλεονεκτήματα [11],[12],[13],[14] της
ανάλυσης βίντεο σε σχέση με τις παραδοσιακές
εργαστηριακές τεχνικές είναι:
1. Η ανάλυση βίντεο απελευθερώνει τους μαθητές
από την πολύπλοκη και χρονοβόρα διαδικασία του
“στησίματος” της πειραματικής διάταξης και της
συλλογής των μετρήσεων αφήνοντας περισσότερο
χρόνο σε δραστηριότητες για την κατανόηση των
διδασκομένων εννοιών. Βέβαια το “στήσιμο” μιας
πειραματικήςδιάταξηςκαιηλήψημετρήσεων
αποτελούν σημαντικό μέρος των δεξιοτήτων που πρέπει
να αποκτήσουν οι μαθητές στοεργαστήριο,και συνεπώς
πρέπεινα υπάρχει ισορροπημένη χρήσητων
παραδοσιακών εργαστηριακών τεχνικών και της
ανάλυσης βίντεο.
2. Η δυνατότητα επανάληψης και ειδικότερα η “καρέ-
καρέ” αναπαραγωγή του βίντεο, συμβάλλει στη
διεξοδικότερημελέτητουκαταγεγραμμένου
φαινομένου και στην ακριβέστερη κατανόηση των
λεπτομερειών του. Αυτό είναι ιδιαίτερα χρήσιμο ειδικά
σε φαινόμεναπου στηφύση εξελίσσονταιπολύγρήγορα
π.χ. ελεύθερη πτώση. Καθοριστικής σημασίας στις
περιπτώσεις αυτές είναι και η χρήση βίντεο που έχουν
ληφθεί σε υψηλή ταχύτητα καρέ και συνεπώς κατά την
αναπαραγωγήτουςδημιουργούν την αίσθησητης αργής
κίνησης.
συντεταγμένων σε συντεταγμένες στον πραγματικό
κόσμο, καθώς και τον υπολογισμό των αντίστοιχων
χρονικών στιγμών.
Στο τέλος της διαδικασίας το λογισμικό έχει εξάγει
δεδομένα θέσης - χρόνου για το κινούμενο αντικείμενο
κατάλληλο λογισμικό ακολουθεί η επεξεργασία τους,
ανάλογα με τον κάθε φορά επιδιωκόμενο διδακτικό
3. Πλεονεκτήματα
•
Ιχνηλατείται κάποιο κινούμενο αντικείμενο που
3. Σε περιπτώσεις δισδιάστατων κινήσεων π.χ. πλάγια
καταγράφεται στο βίντεο, δηλαδή σημειώνεται η
βολή,κυκλικήκίνησηήκινήσεωνστιςοποίες
θέση του στα διάφορα καρέ του βίντεο-κλιπ. Το συμμετέχουν δύο ή περισσότερα σώματα π.χ. πλάγια
λογισμικό αναλαμβάνει μετά τη μετατροπή των
κρούση, οι παραδοσιακές εργαστηριακές τεχνικές είναι
μετρημένωνστηνοθόνητουυπολογιστή
εξαιρετικά δύσκολο ή και αδύνατο να χρησιμοποιηθούν.
Με την ανάλυση βίντεο, δεδομένα και για τους δύο
άξονες της κίνησης μπορούν να ληφθούν, αλλά και δύο
ή ακόμη περισσοτέρων σωμάτων η κίνηση μπορεί να
μελετηθεί στο ίδιο πείραμα.
4. Οι πολλαπλές αναπαραστάσεις που προσφέρουν
στον πραγματικό κόσμο, έχει συμπληρώσει το σχετικό
τα λογισμικά ανάλυσης βίντεο, π.χ. η καρέ-καρέ
πίνακα τιμών και έχει σχεδιάσει τις αντίστοιχες γραφικές
παρακολούθηση της κίνησης ενός αντικειμένου και ο
παραστάσεις. Είτε μετο ίδιο λογισμικό είτε με
ταυτόχρονος σχεδιασμός της γραφικής παράστασης της
μεταφορά των πειραματικών δεδομένων σε άλλο
θέσης του σε συνάρτηση με το χρόνο, βοηθάει τους
μαθητές να δημιουργήσουν τη νοητική σύνδεση μεταξύ
κίνησης και γραφικής παράστασης, διευκολύνοντας την
στόχο.
άρση σημαντικών παρανοήσεων σε σχέση με τις
γραφικές παραστάσεις, όπως ότι μια γραφική
παράστασηαποτελείμιακατάκάποιοτρόπο
φωτογραφική αναπαράσταση της κίνησης κ.ά.
5. Η ανάλυση βίντεο είναι εύκολη στη χρήση της και
δίνει τη δυνατότητα της ενεργού συμμετοχής των
μαθητών τόσο στο σχεδιασμό, όσο και στην εκτέλεση
του πειράματος. Μπορούν για παράδειγμα οι ίδιοι οι
μαθητέςμετοκινητότουςτηλέφωνονα
βιντεοσκοπήσουν μια δραστηριότητά τους, π.χ. το
χτύπημα μιας μπάλας και να αναλύσουν αργότερα το
βίντεο στο εργαστήριο ή στο σπίτι τους, υπολογίζοντας
χαρακτηριστικά της κίνησης π.χ. την ταχύτητα με την
οποία εκτοξεύτηκε η μπάλα. Έχουμε κατ’ αυτό τον τρόπο
τη δυνατότητα να ενεργοποιήσουμε τους μαθητές, ώστε
να ανακαλύψουν τις έννοιες της Φυσικής μέσα από τις
καθημερινές τους δραστηριότητες, αλλάκαινα
μαθαίνουν στο δικό τους χώρο και χρόνο.
6. Η μέθοδος ανάλυσης βίντεο έχει πολύ μικρότερο
οικονομικό κόστος σε σχέση με άλλα πειραματικά
εργαλεία, αφού αρκετά λογισμικά ανάλυσης βίντεο
διατίθενται ελεύθερα από τους δημιουργούς τους, ενώ
στο διαδίκτυο μπορεί να βρεθεί μεγάλος αριθμός
ελεύθερων για χρήση αρχείων βίντεο που είναι
κατάλληλα για ανάλυση.
Το λογισμικό ανάλυσης βίντεο Tracker
Το Tracker είναι ένα ελεύθερο λογισμικό ανάλυσης
βίντεο και μοντελοποίησης. Δημιουργός του είναι ο -
συνταξιούχοςπλέον-καθηγητήςDouglasBrown.
36
Τεύχος 1
,
Ιούλιος 2024
Πρόκειται για μια ανοικτού κώδικα εφαρμογή γραμμένη
σε Java και βασισμένη στη συλλογή εργαλείων Open
κέντρου μάζας) ή σε κάποια άλλη τροχιά (υλικό σημείο)
για τη μελέτη σχετικών κινήσεων, Εικόνα 4.
ψηφιακού βίντεο (mov, avi, mp4,
f
l
v, wmv, κλπ.) και
στατικές εικόνες ήσειρές στατικώνεικόνων(jpg, png, gif).
Συνοδεύεται από ψηφιακή βιβλιοθήκη με έτοιμο για
χρήση υλικό, ενώ με μια σειρά ψηφιακών φίλτρων που
Source Physics. Διαθέτει εγκαταστάτες για Windows, Με μεθόδους αριθμητικής παραγώγισης των
MacOS και Linux, που μπορείτε να τους βρείτε στην πρωτογενών δεδομένων το Tracker μπορεί να εξάγει και
ιστοσελίδα:
ενώ μετά να απεικονίζει στον πίνακα τιμών ή σε γραφική
την έκδοση 6.0 διατίθεται και η online έκδοσή του, ώστε παράσταση δεδομένα ταχύτητας και επιτάχυνσης και εν
να μπορείτε να δείτε τις δυνατότητές του χωρίς να συνεχεία άλλα παράγωγα μεγέθη, π.χ. ορμή, δύναμη,
χρειαστεί να το εγκαταστήσετε στον υπολογιστή σας. κινητική ενέργεια κ.ά. Επιπρόσθετα μπορεί ο χρήστης να
Με το Tracker μπορείτε να αναλύσετε αρχεία ορίσει και άλλα φυσικά μεγέθη, τα οποία δεν υπολογίζει
εξ ορισμού το Tracker, π.χ. τη δυναμική ή τη μηχανική
ενέργεια.
Στην περίπτωση της ανάλυσης στατικής εικόνας, δε
γίνεται ιχνηλασία, αλλά μόνο μετρήσεις με τα εικονικά
ράβδο βαθμονόμησης, τη μετατόπιση αρχής, χρήσιμη
όταν η αρχή του συστήματος αξόνων βρίσκεται έξω από
την εικόνα του βίντεο και τα σημεία βαθμονόμησης που
διαθέτει, επιτρέπει την τροποποίηση της εικόνας του όργανα του Tracker: μέτρηση αποστάσεων με το
βίντεο με ειδικά εφέ ή τη βελτίωση της ποιότητας των εργαλείο “χάρακας”, μέτρηση γωνιών με το
δεδομένων που λαμβάνονται κατά την ανάλυση. “μοιρογνωμόνιο” και μέτρηση των στοιχείων κύκλου
Για τη βαθμονόμηση του βίντεο-κλιπ διαθέτει τρία (συντεταγμένες κέντρου και ακτίνα) με τον
διαφορετικά εργαλεία: τη συνήθως χρησιμοποιούμενη “προσαρμογέα κύκλου”. Ειδική περίπτωση στατικής
εικόνας είναι η χρονοφωτογραφία, η οποία μπορεί να
αναλυθεί αξιοποιώντας την εξ ορισμού δυνατότητα του
Tracker να δημιουργεί δέκα ίδια καρέ από μια στατική
πειραμάτων φασματοσκοπικής ανάλυσης με τη βοήθεια
του εργαλείου (ή “τροχιάς” σύμφωνα με την ορολογία
είναι δεδομένα θέσης-χρόνου, τα οποία εμφανίζονται σε
σχετίζονται με ένα από τα χαρακτηριστικά του Trackerεικόνα. Μετρήσεις σε χάρτες ή σε φωτογραφίες
που το κάνουν να ξεχωρίζει από τον ανταγωνισμό:γεωλογικών σχηματισμών ή σε -μέσω μικροσκοπίου-
Πρόκειταιγιατηδυνατότηταπραγματοποίησηςφωτογραφίεςμικροοργανισμώνμπορούννα
πραγματοποιηθούν εύκολα με τη χρήση αυτών των
οργάνων.
του Tracker) “προφίλ γραμμής”. Άλλα πειράματα με φως Εκείνη όμως η δυνατότητα που πραγματικά ξεχωρίζει
μπορούν να πραγματοποιηθούν με την τροχιά “περιοχή το Tracker από αντίστοιχα εμπορικά ή ελεύθερα
RGB”μέσω της οποίας το Tracker μπορεί να προσδιορίσει λογισμικά είναι η δυνατότητα δημιουργίας του
τη φωτεινότητα μιας μικρής περιοχής στα διάφορα καρέ κινηματικού ή δυναμικού μοντέλου για το φαινόμενο
του βίντεο. Και οι δύο αυτές δυνατότητες είναι -εκτός που μελετάμε. Ουσιαστικά, εισάγοντας στο σχετικό
των άλλων- χρήσιμες και στην πειραματική διδασκαλία εργαλείο του Tracker τις χρονικές εξισώσεις των
θεμάτων Χημείας. συντεταγμένων θέσης (για το κινηματικό μοντέλο) ή τις
Η ιχνηλασία ενός κινούμενου αντικειμένου που αρχικές συνθήκες και τις εξισώσεις των συντεταγμένων
καταγράφεται στο βίντεο μπορεί στο Tracker να γίνει είτε δύναμης (για το δυναμικό μοντέλο) το λογισμικό
χειροκίνητα είτε αυτόματα. Περισσότερα του ενός υλικά υπολογίζει τις συντεταγμένες θέσης με βάση το
σημείαμπορούν να ιχνηλατηθούν διαδοχικά,αλλά καινα θεωρητικό μοντέλο και επισυνάπτει τα αντίστοιχα ίχνη
προσδιοριστεί και ιχνηλατηθεί το κέντρο μάζας τους. Τα σε όλα τα καρέ του βίντεο-κλιπ, επιτρέποντας την άμεση
πρωτογενή πειραματικά δεδομένα από την ιχνηλασία σύγκριση πραγματικού φαινομένου-θεωρητικού
μοντέλου, Εικόνα 4.
πίνακα τιμών και σε σχετικές γραφικές παραστάσεις.
Για την ανάλυση των πειραματικών δεδομένων το
Για τον προσδιορισμό της θέσης των τροχιών το TrackerTracker ενσωματώνει το “Εργαλείο δεδομένων”, στις
δημιουργεί ένα σύστημα συντεταγμένων, του οποίουδυνατότητες του οποίου είναι:
μπορούμε να αλλάζουμε και τη θέση της αρχής του και
•
Η δημιουργία μιας ή περισσοτέρων γραφικών
τονπροσανατολισμότωναξόνωντου.Επιπλέον
π
αρ
αστά
σεωνμεβ
ά
ση
τ
αμ
ε
γ
έ
θηπ
ο
υέ
χ
ει
μπορούμε να προσαρμόζουμε την αρχή π.χ. στο κέντρο
υπ
ολογίσ
ει το
Tr
a
ck
er
κατ
ά τ
η
ν
ι
χ
νηλα
σία ή άλ
λ
ων
μάζας ενός συστήματος υλικών σημείων (σύστημα
37
Τεύχος 1
,
Ιούλιος 2024
πουστοίδιοτοεργαλείομπορούμενα
δημιουργήσουμε.
•
Η λήψη μετρήσεων κατευθείαν πάνω στις γραφικές
παραστάσεις(π.χ.συντεταγμένες,κλίσησε
Εννοείται βέβαια πως τα πειραματικά δεδομένα
μπορούν να εξαχθούν σε αρχείο κειμένου, ώστε η
ανάλυση να γίνει με τη βοήθεια κάποιου άλλου
λογισμικού, π.χ. με το EXCEL.
Στα πλεονεκτήματα του λογισμικού Tracker πρέπει να
αναφερθεί πως το περιβάλλον του είναι εξελληνισμένο.
Υπεύθυνος για την ελληνική μετάφραση είναι ο Κύπριος
Φυσικός Δρ. Γεώργιος Τσαλακός.
Τέλος είναι σημαντικό να αναφερθεί η συνεισφορά
της ΠΑΝ.Ε.Κ.Φ.Ε. ως προς την επιμόρφωση των
συναδέλφων στην ανάλυση βίντεο και το Tracker, με τα
σεμινάρια που υλοποίησε κατά τα έτη 2023 και 2024,
καθώς και με το επιμορφωτικό υλικό που παράχθηκε για
το σκοπό αυτό. Το υλικό αυτό είναι ελεύθερα διαθέσιμο
και οι σχετικοί σύνδεσμοι δίνονται στο πρόσθετο υλικό
που συνοδεύει το άρθρο.
Συμπεράσματα
Ηανάλυση βίντεοδιαθέτει σημαντικά πλεονεκτήματα
σε σχέση με τις παραδοσιακές εργαστηριακές τεχνικές,
αν και δεν υποστηρίζει δεξιότητες που σχετίζονται με το
στήσιμο της πειραματικής διάταξης και την άμεση λήψη
μετρήσεων. Το ελεύθερο λογισμικό ανάλυσης βίντεο
Tracker διαθέτει πληθώρα εργαλείων βαθμονόμησης και
μετρήσεων, διάφορα είδη “τροχιών” για την αυτόματη ή
χειροκίνητηιχνηλασία,ικανοποιητικέςδυνατότητες
ανάλυσης των πειραματικών δεδομένων, καθώς και
κάποιαιδιαίτερα χαρακτηριστικά, όπωςη
μοντελοποίησηκαιηχρήσητουσε πειράματα
φασματοσκοπίας, που το κάνουν να ξεχωρίζει ακόμη και
από αντίστοιχα εμπορικά προϊόντα. Παρότι το Tracker
εμφανίζει τον “καλύτερο εαυτό” τoυ στη Φυσική και
ειδικότεραστηνανάλυσηκινήσεων,μπορείνα
χρησιμοποιηθεί και σε άλλους τομείς της Φυσικής π.χ.
στην οπτική, αλλά και στις άλλες Φυσικές Επιστήμες.
προσαρμογήςσταπειραματικάδεδομένα,
επιλέγοντας από μια σειρά έτοιμων συναρτήσεων ή
ορίζοντας εμείς τη συνάρτησητης καλύτερης
καμπύλης.
οποιοδήποτε σημείο, εμβαδό).
•
Οπροσδιορισμόςτηςκαλύτερηςκαμπύλης
Βιβλιογραφικές Αναφορές
[1]Collins, A., & Halvestron, R. (2010). The second educa
t
ional revolu
t
ion:
rethinking educa
t
ion in the age og technology. Journal of Computes
Assisted Learning(26), σσ. 18-27.
[2]BECTA. (2004). A review of the research literature on barriers to the
uptakeofICTbyteachers.Ανάκτησηαπό
[3] Ditzler, C., Hong, E., & Strudler, N. (2016, May). How Tablets Are U
t
ilized
in the Classroom. Journal of Research on Technology in Educa
t
ion.
[4]CAID. (2017). Digital technologies in the classroom. Ανάκτηση 2024, από
CambridgeAssessmentInterna
t
ionalEduca
t
ion:
[5]Cope, W., & Kalantzis, M. (2007). New media, new learning. Τηε
Interna
t
ional Journal of Learning: Annual Review, 14, σσ. 75-80.
[6]Richtel, Μ. (2011). In Classroom of Future, Stagnant Scores. Ανάκτηση
2024,απόNewYorkTimes:
[7]Wikipedia. (2005). Eadweard Muybridge. Ανάκτηση 2024, από
[8]Chazot, C. (2023). Mo
t
ion analysis using chronophotography. Ανάκτηση
2024,απ
[9]Beichner, R. J. (1996). The impact of video mo
t
ion analysis on kinema
t
ics
graph interpreta
t
ion skills. American Journal of Physics, 64.
[10] Brown, D., & Cox, A. J. (2009, February). Innova
t
ive Uses of Video
Analysis. The Physics Teacher, 47.
Εικόνα 4. Μοντελοποίηση ελεύθερης πτώσης με το Tracker
38
Τεύχος 1
,
Ιούλιος 2024
[11] Escalada, L. T., & Zollman, D. A. (1997, 5). An Inves
t
iga
t
ion on the Effects of
Using Interac
t
ive Digital Video in a Physics Classroom on Student
Learning and Atitudes. Journal of Research in Science Teaching (34), σσ.
467-489.
[12] Laws, P., & P
f
i
ster, H. (1998, May). Using digital video analysis in
introductory mechanics projects. The Physics Teacher (36)
[13] Τσαλακός, Γ. (2011, Οκτώβριος). Η αξιοποίηση της ανάλυσης βίντεο στο
μάθημα τηςΦυσικής. ΔελτίοΠαιδαγωγικούΙνστιτούτουΚύπρου,σσ. 19-
25.Ανάκτησηαπό
[14] Νούσης, Β. (2014). Tracker Λογισμικό ανάλυσης βίντεο - Πειράματα
Φυσικής Α΄ Λυκείου. Ηγουμενίτσα: Αυτοέκδοση. Ανάκτηση από
Πρόσθετο υλικό
Video για ανάλυση και επιμορφωτικό υλικό μπορείτε να βρείτε εδώ:
•
•
•
•
•
•
Υλικό για πειράματα Χημείας-Βιολογίας μπορείτε να βρείτε εδώ:
•
Βιογραφικό συγγραφέως
Ο Βασίλης Νούσης ζει και εργάζεται στην
Ηγουμενίτσα, Θεσπρωτίας. Είναι πτυχιούχος
του Τμήματος Φυσικής της Σχολής Θετικών
Επιστημών του Πανεπιστημίου Ιωαννίνων.
Απέκτησε μεταπτυχιακό δίπλωμα στις "Νέες
τεχνολογίες και έρευνα στη διδακτική των Φυσικών
Επιστημών" από το ίδιο τμήμα. Από το 1996 διδάσκει Φυσικές
Επιστήμες (Φ.Ε.) στη Δευτεροβάθμια Εκπαίδευση, ενώ από το
•
2011 είναι υπεύθυνος του ΕΚΦΕ Ηγουμενίτσας. Στα
ενδιαφέροντά του είναι η αξιοποίηση στοιχείων από την
ιστορία των Φυσικών Επιστημών και των νέων τεχνολογιών
στην πειραματική διδασκαλία των Φ.Ε.
39
Τεύχος 1
,
Ιούλιος 2024
Πίνακας Περιεχομένων
Ταλάντωση αγώγιμων σφαιρών πάνω σε φορτισμένο ηλεκτροφόρο13
Αύξηση διαφοράς δυναμικού στην απομάκρυνση πλακών πυκνωτή14
Παράρτημα 3.16
Ταλάντωση μπίλιας μεταξύ δυο ηλεκτροφόρων με αντίθετα φορτία13
Σημειώσεις17
Φόρτιση ηλεκτροσκοπίου.14
Παράρτημα 2.15
Παράρτημα 1.15
Συμπεράσματα17
Ηλεκτρική εκκένωση με το δάχτυλο13
Φύλλο εργασίας ηλεκτροφόρου12
Φόρτιση ηλεκτροφόρου12
Εditorial2
Σημείωμα Συντακτικής Ομάδας2
Σχετικά με το Περιοδικό2
Νίκος Αναστασάκης3
Η διδασκαλία των Φυσικών επιστημών:3
Εισαγωγή4
Επέκταση του εργαστηρίου στη σχολική τάξη4
Οι πειραματικές δραστηριότητες5
Αξιολόγηση της διδακτικής στρατηγικής7
Συμπεράσματα7
Βιβλιογραφικές Αναφορές8
Δικτυακοί τόποι:8
Βιογραφικό συγγραφέως8
Βαγγέλης Βάρθης9
Ηλεκτροφόρος:9
Βιογραφικό συγγραφέως17
Ευχαριστίες17
Αναστασία Γκιγκουδη - Αγαθονίκη Μαμζερίδου18
Με πειράματα ηλεκτρισμού ανακαλύπτουμε τη δομή της ύλης:18
Εισαγωγή
19
Διδακτική πρόταση
20
Μεθοδολογία
20
Συμπεράσματα
21
Έρη Παπαδέλλη
23
Προσομοιώνοντας τη λειτουργία του κυκλοφορικού συστήματος και τη σύσταση του
αίματος
23
Περιγραφή παρέμβασης
25
Αποτελέσματα
26
Συμπέρασμα
26
Βιβλιογραφικές Αναφορές27
Πρόσθετο υλικό27
Βιογραφικό συγγραφέως27
Σταυρούλα Γατή - Ελένη Παλούμπα28
Σχολική Σαπωνοποίηση:28
Εισαγωγή29
Αφόρμηση29
Κατάρτιση Σχεδίου Δράσης - Engineering30
Παρασκευή Σαπουνιού–STEM30
Συσκευασία–διαφήμιση31
Mathematics, Art, Technology, Engineering31
Αξιολόγηση – διάχυση31
Συμπεράσματα31
Βιβλιογραφικές- Διαδικτυακές Αναφορές32
Πρόσθετο υλικό32
Βιογραφικά συγγραφέων32
Βασίλης Νούσης33
Ανάλυση βίντεο:33
Εισαγωγή34
Η ανάλυση βίντεο34
Το λογισμικό ανάλυσης βίντεο Tracker36
Συμπεράσματα38
Πρόσθετο υλικό39
Βιογραφικό συγγραφέως39